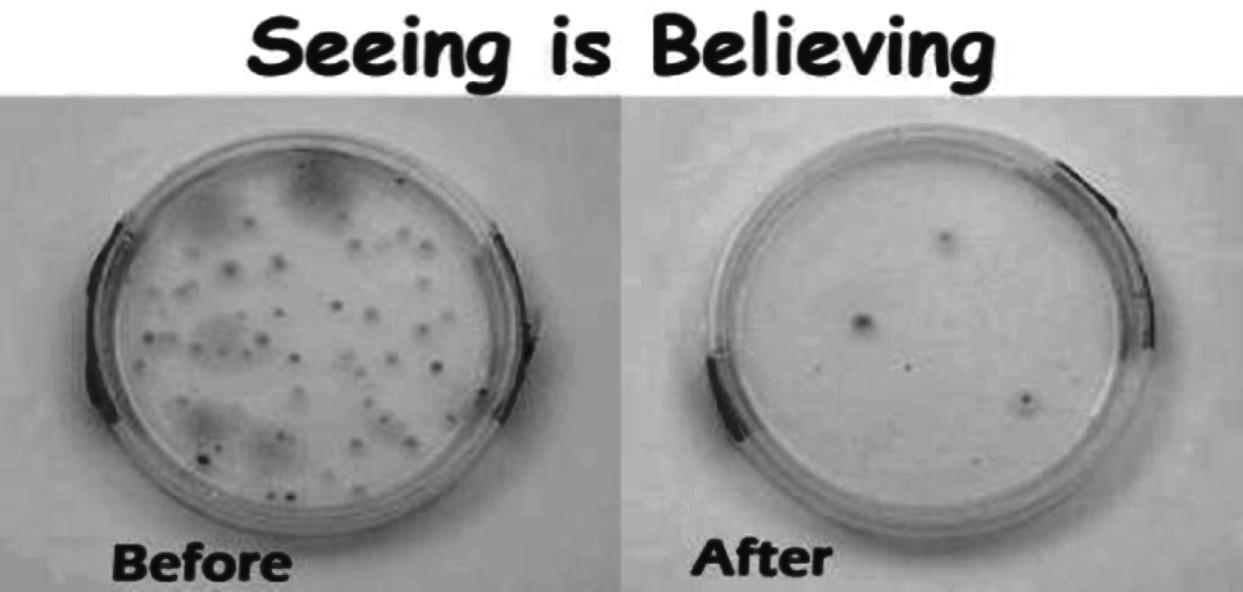

Opinion
Schools
Spor ts


![]()




By Mark Lioi Town-Crier Staff Report
In a year that began with the deflation of the long-running local housing boom and ended with the entire nation reeling from the effects of an ongoing economic meltdown, it’s no surprise that money played a key role in many of the top local stories of 2008.
But while many of the stories that played out in Wellington featured impassioned participants taking sides on divisive issues, northern neighbor Royal Palm Beach held mostly steady and faced conflicts not among its own, but beyond its borders.
The councils of both villages saw a change of members. In Royal Palm Beach, Martha Webster won a three-way race in January to fill a long-vacant council seat, despite the endorsement of one of her opponents by three sitting council members. Fears that Webster, a sometimes outspoken RPB critic, would sour the customarily collegial council proceedings have so far proved unfounded. Meanwhile, the most stunning outcome of three council seat races in Wellington was the March ouster of village icon Tom Wenham as mayor in favor of Darell Bowen by a 60-40 margin. Bowen, previously president of the Wellington Chamber of Commerce, prom-
ised to bring a more businesslike approach to running village affairs. Firefighter Matt Willhite picked up the council seat vacated by Laurie Cohen, and, as usual, Dr. Carmine Priore won easy re-election.
When officials from Palm Beach Community College came to town a month later with an offer to build the institution’s fifth campus in Wellington, Bowen was quick to embrace the proposal. Only one problem, critics of the plan maintain — the village is poised to basically give away some 67 acres of prime State Road 7 real estate worth $20 million or more to provide the college a new home. At the close of the year, the deal is not yet done, but some observers suggest it is a done deal, while others cry “stop the madness.”
And it was money, or rather the lack of it, that made the land available and gave it a campusworthy appearance in 2008. Wellington bought the land in 2003 with eyes for a crown-jewel park facility, but shrinking revenues brought on by tax-reform measures and the housing bust made the development of such a facility less likely as the village began taking a hard look at its budget this year.
The budget Wellington ultimately passed in September saw the elimination of 13 full-time

18th Annual Children’s Holiday Fishing Classic was held at the Wellington Community Center dock on Satur-

By Ron Bukley
Town-Crier Staff Report
Wellington government leaders are unhappy that the Solid Waste Authority is leaving them and other area communities out of a promised role in selecting the site for a new regional landfill.
The existing landfill at Jog Road and 45th Street is expected to reach capacity in less than 15 years, and the SWA has backed off of plans to develop a new one on land it owns directly to the west of the Arthur R. Marshall Loxahatchee National Wildlife Refuge due to environmental concerns, Wellington Village Manager Paul Schofield explained.
“The environmental community objected to the site adjacent to the conservation area because of the potential impact on what many view as the final remnants of the original Everglades,” Schofield told the Town-Crier Monday. “We understand that, we have no problem with that, but you’ve got to have landfills. There’s no way we’re not going to have landfills. You can eliminate or minimize impact on significant natural resources. That should be done. We’re not arguing about that at all.”
Instead the SWA is examining the potential of three privately owned properties offered to house the new landfill and has already ranked them, but Schofield and other community leaders argue that the SWA has not been above board in the selection process.
The site preferred by the SWA selection committee is the Smith property directly at the northwest corner of the intersection of Southern Blvd. (State Road 80) and Route 98, Schofield said. The other sites are the Hundley property on SR 880 south of Southern Blvd. and the
Okeelanta property on the western edge of the county.
“The committee ranked the Smith site as the number-one site,” Schofield said. “There were supposed to be public hearings. There have been no public hearings. They have not been out in the western communities talking to us about where that site is or what its impacts on us are going to be. What we have now is the site ranked number one sitting directly on Southern Blvd.”
Schofield said he feels the residents who will suffer most if the Smith site is chosen will be those who live near Lake Okeechobee, who he said don’t need a dump site right on the only eastwest thoroughfare to their communities.
“The useful life of a landfill is about 50 years,” Schofield said. “It would be sort of like driving by the dump site on the turnpike. It is right there.”
Schofield said a location several miles off Southern Blvd., like the Hundley site, would pose less of a visual distraction.
“You could move it a couple of miles off the road and screen it,” Schofield said. “It doesn’t particularly increase the costs. The only thing we’re asking is that the Solid Waste Authority do what it promised it would do: to come out and have community meetings. They haven’t done that yet. Our council passed a resolution back in July opposing the site directly on Southern Blvd. Royal Palm Beach passed one also. Everybody knows you have to have it, but let’s find a place to site it that has the least impact.”
The Solid Waste Authority Governing Board, which is composed of the members of the Palm Beach County Commission, will hold a public hearing on selecting a new landfill site
on Jan. 14 at its headquarters at 7501 N. Jog Road in West Palm Beach. Although legal notice has been given, the hearing has not been highly publicized, Schofield said, adding that people seeking information about the meeting have to dig for it. Wellington Councilwoman Lizbeth Benacquisto said she feels the SWA should have given more notice.
“We were a little surprised that the Solid Waste Authority called a special meeting for Jan. 14 and did not advise any of the municipalities or the affected residents,” Benacquisto told the Town-Crier Monday. “We were surprised at that because we had been working with them, we thought, very well over the last couple of months, making sure that we as a city stay informed. That’s why we’re sounding the alarm. We want everybody to have the opportunity to voice their displeasure.”
Schofield said the SWA needs to be more open.
“If this is the right thing to do, let’s do it out in the light of day,” he said. “I believe that in a decision as important as the location of a landfill that will serve this county for the next half century, the impact of the placement of that facility on the future of the lake communities should be considered. The impact on people using the only east-west road within 60 miles in either direction should be considered.” Schofield said he considers the Okeelanta site unrealistic unless a way is figured out to ship garbage there by rail. The Hundley and Smith sites are centrally located, but they will have a major impact on Southern Blvd. traffic, Schofield said. Schofield said the likelihood of a new western landfill drawing unplanned development also
LANDFILL, page 21

By Ron Bukley
Staff Report
Paul about families that might be in need.
“I approached the principal because he rides his golf cart past the station every day,” Sousa recalled. “He turned me on to Kelly Mills, the guidance counselor at Binks Forest Elementary School.” Franceline







By Carol Porter Town-Crier Staff Report
The year 2008 was an extraordinary one for the South Florida Water Management District, and one of the district’s leading officials met with members of the Loxahatchee Groves Landowners’Association last week to put it all in perspective.
Fred Rapach, director of the SFWMD’s Palm Beach County Service Center, spoke to LGLA members at their Dec. 18 meeting. The year began with the state in the grip of a drought that continued to worsen, and Rapach said the SFWMD made educating water users about the drought and how to conserve water a top priority.
“We had a good public relations outreach effort going on,” he said. “We put together 20 drought management teams, and we did weekly in-depth analyses and extensive utility drainage district coordination. We did all kinds of outreach efforts. We did several publications just to make sure that everyone knew what was going on.”
But the district also took advantage of an extraordinarily low water level in Lake Okeechobee to get work done during the drought, Rapach said. “We started to do some demucking of organic materials,” he said. “We relocated trees. We even found tires. Once the water came down, we found about 50 tons of discarded tires.”
Rapach said that as summer came, his colleagues at the SFWMD were hopeful that a significant tropical system would deliver enough rainfall to alleviate the severe drought conditions, and that Tropical Storm Fay filled the bill in August, although it made the lives of several thousands of Floridians miserable.
“You look at the district-wide rainfall,” he said. “There was over a seven and a half inches of rain in some areas, and in Martin and St. Lucie [counties], there was in excess of 20 inches of rain. It was amazing.”






Another year has come and gone. This holiday, take time with your friends and family to reflect on memories past and opportunities ahead.
So that our employees may enjoy the holiday with their loved ones, MedExpress will be closed on December 25, 2008.





While the SFWMD was also busy in projects that involved reduction of phosphorus content in surface water and Everglades restoration work, Rapach singled out the completion of the Lake Region Water Treatment Plant to serve residents of Pahokee, Belle Glade and South Bay. The $55 million plant draws water from the Floridan Aquifer rather than Lake Okeechobee, he said.

as restricting travel and conference attendance. He said the district would also continue to stress conservation in water use. Seen by much of the public simply as restrictive measures, he said conservation should be seen in a more positive light.
“Conservation is essentially a good thing to do,” Rapach said. “You need to conserve a resource and use it wisely, and that’s a positive thing. It doesn’t mean doing without. It means using it and not wasting it. That’s how we conserve a resource. That’s a good thing.” Rapach also expressed hope about the conclusion of a deal by the district and the state to buy more than 180,000 acres of U.S. Sugar land for Everglades restoration and better water management in South Florida. The proposed $1.34 billion purchase is the culmination of more than five months of complex negotiations and extensive due diligence on the part of the SFWMD including multiple land appraisals, environmental assessments and engineering evaluations.
LGLA member Pat Johnson asked Rapach if the district would have to pay for the cleanup of the land, and if so, how much. Rapach said U.S. Sugar would be required to bring the land to a basic standard, and that the SFWMD would do further work where necessary.
“U.S. Sugar will pay for some of the cleanup,” Rapach said. “They will clean it up to a certain level. Different levels of cleanup would be required.” While a recent counteroffer has come from a giant farming corporation seeking the land, complicating the prospects of completing the deal, Rapach also noted that the district also must wait on the State Legislature before it can be certain the money for the purchase will be made available.


“It is providing water to the tri-cities area,” Rapach said. “Its main goal was to move the cities off of Lake Okeechobee as a source of water. The lake had high organics, and a lot of material in it. It was a pain in the neck to clean it.”










Currently the SFWMD is taking part in the general suffering from the effects of shrinking revenues and a struggling economy, Rapach said, and is seeking ways to cut back and eliminate unnecessary spending, such
“We have the 2009 legislative session to go through,” Rapach said. “I am sure there will be a lot of discussion on that. As you know, they have a special session right after the New Year to look at the state budget. There will be a lot of discussion on that. They are $2 billion in the red starting out. We will have to wait and see how this plays out, but I think it’s an excellent opportunity.”


Christmas came early to Lion Country Safari on Thursday, Dec. 18. In the safari’s “Christmas with the Chimps” tradition, Santa arrives at the chimp compound by boat to deliver presents. Gifts included stuffed animals, clothes, snacks and more.



















“The chimpanzees are as excited as you or I about receiving their Christmas presents,” Wildlife Director Terry Wolf said. “The fact that they are such highly intelligent primates makes it necessary for us to always go that extra mile to provide them with highly stimulating environmental enrichments.” (Above right) Santa and Terry Wolf head to the island. (Below right) Melody opens her












This week, State Representative Joseph Abruzzo (D-District 85) filed his first two pieces of legislation: HB 167, the Consumer Energy Savings Bill, and HB 169, an act that would require minors 16 and under to wear a helmet when riding horses. During the last two weekends in July, the Consumer Energy Savings Bill would give an eight-day sales tax holiday for select Energy Star equipment in the State of Florida.
“The bill accomplishes three goals,” Abruzzo said. “One, it boosts the economy by raising retail sales in one of the lowest periods; secondly, it contributes to energy savings and consumer costs; thirdly, it is environmentally friendly.” HB 169 would require minors 16 and under to wear helmets while riding horses. “HB 169 is a common sense policy proposal that will benefit families and save lives. I file this bill in memory of Nicole Hornstein and all children who have lost their lives or who have suffered significant injury while riding horses,” Abruzzo said. Hornstein was a 12-year-old Acreage girls who died in a tragic horse riding accident in June 2006. A similar bill filed by Abruzzo’s predecessor Shelley Vana passed the State House of Representatives last spring but failed in the State Senate.
On Thursday, Dec. 18, My Brother’s/Sister’s Keeper
Charitable Trust partnered with the Palm Beach County Sheriff’s Office and Wal-Mart to assist 100 families from the Glades communities. Deputies from the PBSO’s Community Policing Division were on hand to shop with a member of each of the 100 families at the Wal-Mart SuperCenter on Belvedere Road in Royal Palm Beach. Each representative received a $100 gift card to purchase basic necessities for their families. The money was used to purchase essentials such as food for holiday meals and clothes for children.





As is our year-end custom, the TownCrier newspaper ends 2008 with some very special New Year’s wishes for our leaders, institutions and other notaries.
To truly enjoy life, it takes a sense of humor… and we certainly hope those caught in our cross-hairs enjoy our irreverent thoughts with a smile on their face. A Happy New Year to all our loyal readers, and we’ll be back with more serious commentary in 2009.
Retired Wellington Village Manager Charlie Lynn: A second career as a psychic, advising people exactly when to move on.
Wellington Mayor Darell Bowen: A sign at K-Park that reads, “The PBCC Darell Bowen Campus.”
Wellington Vice Mayor Dr. Carmine Priore: A state constitutional change that puts the president of the Florida League of Cities in the governor’s cabinet.
Wellington Councilwoman Lizbeth Benacquisto: A four-year college with a strong desire for a full-scale Wellington campus.
Wellington Councilman Bob Margolis: A fun time on his “year-long vacation.”
Wellington Councilman Matt Willhite: A new friend on the council.
The Wellington Village Council: Consensus on a replacement for Bob Margolis.
Wellington Chamber President
Mike Nelson: A council seat with his name on it.
Have you thought about a landfill lately? If you haven’t, the Solid Waste Authority is thinking about one, and they are thinking of locating it on Southern Blvd. Have you thought about how a new landfill on Southern Blvd. will affect our communities and our neighbors?
The Solid Waste Authority has scheduled a special meeting on Jan. 14 at 10 a.m. to consider the location for the new “western county landfill.” Their top choice is a site that sits directly on Southern Blvd. and U.S. 98. The SWA promised to seek community input, they have not, it is time to let the SWA and the [Palm Beach] County Commission know what the community thinks. It is time to make our voices heard.
In July, the Wellington Village Council passed a resolution opposing the dump site on Southern Blvd. and supporting the site that the SWA currently owns.
The objections were based on human and environmental impacts that will exist far longer than the anticipated 50-year life span of the dump. Quoting the council, “if a new landfill site must be selected, then the selec-
Palm Beach Community College: Money to actually build the Wellington campus they are proposing.
Wellington Council Opponents: The ability to call a snap referendum whenever they want.
Wellington Village Manager Paul Schofield: A Harley on standby at the back door of the Wellington Community Center… and three envelopes.
Former Wellington Mayor Tom Wenham: A special program at the Betty Ford Clinic on overcoming photo op withdrawal.
Wellington Attorney Howard Coates: An election he can actually manage to win.
Horse Show Promoter Mark Bellissimo: More crowds than he can handle.
The Royal Palm Beach Village Council: A high-visibility, low-cost 50th anniversary party… and a way to lower the tax rate yet again next year.
Royal Palm Beach Mayor David Lodwick: A fortune-teller to advise him whether to seek re-election in 2010 or retire to his home in North Carolina.
Royal Palm Beach Vice Mayor Fred Pinto: That County Commissioner Jess Santamaria anoints him as his successor.
Royal Palm Beach Councilman
Matty Mattioli: Another 15 years on the council.
Royal Palm Beach Councilman
David Swift: A traffic circle in his driveway.
tion process should take place in the open and with the full knowledge and input of the residents of the western communities.”
If the idea of building the next landfill directly on Southern Blvd. disturbs you, please contact the Solid Waste Authority and the county commission:
• Mark Hammond, Palm Beach County Solid Waste Authority, 7501 North Jog Road, West Palm Beach, FL 33412; (561) 640-4000; contactCIS@ swa.org
• Board of County Commissioners, 301 N. Olive Avenue, Suite 1102, West Palm Beach, FL 33402; (561) 355-2754; public@co.palm-beach.fl.us. Councilwoman Lizbeth Benacquisto Wellington Is Our
Government of the people, by the people, for the people. The Wellington Village Council should take heed and revisit this timeless concept.
After the council decided to vaguely merge the recreational and travel baseball programs under one umbrella, a few fathers and myself took our 11and-under travel team and decided to go out on our own. I had numerous meetings with the
Royal Palm Beach Councilwoman Martha Webster: A free pass for re-election after years of campaigning.
Royal Palm Beach Village Manager David Farber: Plenty of sponsors for RPB’s 50th anniversary party and no need to break in new council members.
County Commissioner Jess Santamaria: Six other commissioners that see things his way.
County Commissioner Shelley Vana: Better luck than Warren Newell and Bob Kanjian, the last two people to have sat in her seat.
Palm Beach County Administrator Bob Weisman: A long-forgotten county fund with a few hundred million dollars just lying around.
Palm Beach County Sheriff Ric Bradshaw: A year without gangs.
Palm Beach County State Attorney Michael McAuliffe: The ability to turn “do more with less” from a tired cliché into reality.
Incoming Palm Beach County Supervisor of Elections Susan Bucher: Elections that keep her out of the headlines.
Loxahatchee Groves Mayor Dave Browning: A brokered settlement to his community’s civil war.
Loxahatchee Groves Vice Mayor Marge Herzog: R-E-S-P-E-C-T.
Loxahatchee Groves Councilman
Dr. Bill Louda: Veto over landfills and power plants.
Loxahatchee Groves Councilman
Dennis Lipp: A candidate to run against Vice Mayor Marge Herzog. Plus, for his future plans, see Fred Pinto. Loxahatchee Groves Councilman
Dave Autrey: A clean bill of health in the New Year… and the right to appoint his successor. The Loxahatchee Groves Water Control District: Gas tax money to call its own.
Indian Trail Improvement District
President Michelle Damone: Now that she has wrestled her old position back from Mike Erickson, to be named president for life.
Indian Trail Improvement District
Supervisor Mike Erickson: Some personal time now that he doesn’t have to go to every meeting under the sun.
Indian Trail Improvement District
Administrator Chris King: A board that stays under control and out of the headlines.
The Western Communities: A landfill someone else can call its own.
Florida Gov. Charlie Crist: A time machine for John McCain to go back four months and reconsider.
State Sen. Dave Aronberg: Jeb Bush’s decision not to run for the U.S. Senate.
State Senate President Jeff Atwater: Jeb Bush’s decision not to run for the U.S. Senate.
State Rep. Mark Pafford: As easy a time passing bills in Tallahassee as he had getting elected.
village and was more than happy to pay the rental fee of $50 to $100 per hour plus an additional $30 for lights. I was told, however, that there were no fields available to rent. If this is true, and why wouldn’t it be, I ask my council members this simple question: how can you give away 67 acres of prime real estate that was intended for future ball fields? (Let’s dispense with the “lease” notion; any institution that can lease 67 acres at $1 per year needs to call it what it really is — a “giveaway.”) The council members are our representation in all matters Wellington; we chose them to make decisions for us. OK, fair enough, but then why aren’t they listening to us? Most people don’t even know the details of the Wellington/Palm Beach Community College/K-Park deal. It has been a shadowy discussion at best. Do we all know that the land may not, in fact, be free and clear? There may be a bond issue that we the taxpayers will be responsible for paying off. Do we know that PBCC has continually rejected the terms of the lease, especially when Village Attorney Jeff Kurtz threw in the clause asking for $1 million per year after 25 years? Do we know that there has been no appraisal of the land as of yet? Do we know that the
idea of a referendum has been continually rejected by the council? What are they afraid of finding out? Why not ask the people what they want? And yet our representatives are happily negotiating to give it all away!
I am a longtime supporter of recreation in the village. I was impressed with the village’s foresight in creating the levels of service (one acre of recreational use per 1,000 people). Now, however, the council has decided somehow — I can’t find when and where — that that standard no longer exists. When did they manage to change that? K-Park was purchased to meet those levels. Now suddenly we no longer have that standard? And by the way, why not hang on to the land as a safety net for future economic troubles?
Yes, the council does in fact make decisions for us, but they should based on what we want, not what individual council members want. I ask Councilwoman Lizbeth Benacquisto to consider that her vision of a college in Wellington be met in its entirety before voting yes to something that vaguely resembles what she wants. I ask Vice Mayor Dr. Carmine Priore to recall his fiscally conservative nature of the past and to remember that these are tough times. I ask Councilman Bob Margolis to fall back on his recreational
State Rep. Joseph Abruzzo: A legislature that takes his ideas seriously.
State Rep. Carl Domino: A housing market that makes his hard-fought homestead portability measure useful.
The Florida Legislature: More revenue without needing to raise taxes.
Disgraced Congressman Tim Mahoney: Congrats on his appointment as partner in the lobbying firm Liberti, Masilotti, Foley, Newell & Mahoney. Congressman-Elect Tom Rooney: A chastity belt… and a chance to prove that the District 16 seat isn’t cursed.
National Healthcare Reform: Life despite an economic crisis.
Palms West Chamber CEO Jaene Miranda: The groundbreaking she has always dreamed of.
President-Elect Barack Obama: An amazing ability to multi-task.
The U.S. Economy: An unexpected, amazing recovery.
The Big Three Automakers: A line of cars people want to buy.
U.S. Senator Mel Martinez: A retirement more successful than his brief Senate career.
Florida Democrats: A statewide leader with star power enough to defeat the Jeb Bush Senate Express.
Florida Republicans: A State House Speaker and the State Senate President who actually see eye to eye.
Financial Scammer Bernie Madoff: A lifetime stay in Club Fed… and a way to make restitution for the disaster he has wrought.
roots and stick to his no vote. I ask Councilman Matt Willhite to remember that his no vote is the cornerstone to stopping this giveaway. And finally, I ask Mayor Darell Bowen to listen to the majority of the people, not the non-village residents who turn up to one council meeting to voice their approval for this deal. After all, at the end of the day, this is a Wellington matter, not a western communities issue.
Remember, council members, despite what you think is best, you still have to listen to your constituents… and we are asking that you emphatically vote no to the giveaway of K-Park to the Palm Beach Community College. We, the people, have spoken, are our representatives listening?
Craig Brown Wellington
[Wellington Councilman
Bob] Margolis should not be allowed to play musical chairs
with his elected position. First he wants to run for [Palm Beach County Supervisor of Elections], but thank goodness the people of the county thought otherwise, by a large margin. Apparently his political dartboard has him considering a run for a possible county commissioner’s seat that could open up (say it ain’t so, Jess) or failing that, the village mayor’s position in our next election cycle. He fails to understand that the election of Darell Bowen was a vote against the past wasteful spending and new priorities, precisely not what Mr. Margolis represents. Mr. Margolis was one of the prime movers in firing an allvolunteer (council-appointed) code board and replacing them with a lawyer. I find that unAmerican, because whenever possible, we should be judged by our peers. He was a singleissue candidate, and I have seen little leadership from him. The voters of Wellington want consistency. Why vote for a man who appears to be run-
The Town-Crier welcomes letters to the editor. Please keep letters brief (300 words). Submit letters, with contact name, address, and telephone number (anonymous letters will not be published), to The Town-Crier, 12794 W. Forest Hill Blvd., Suite 31, Wellington, FL 33414; fax them to 793-6090; or you can e-mail to letters@ goTownCrier.com.
I’m Finally Going Pro... You Can Now Call Me ‘Mr. Curmudgeon’
I’m going pro on Jan. 2. That’s the day I turn 65, when I will leave the amateur ranks and become certified as a professional curmudgeon. On that day, I will no longer have to apologize to anyone for being skeptical about most things and opinionated about everything.
It’s a day I’ve looked forward to since turning 50. Why 50? Because then I didn’t view the world much different than I do now, but people don’t pay much attention to younger curmudgeons. Once we reach 65, we get the respect we knew we always deserved.
What exactly is a curmudgeon? Merriam-Webster’s short definition is a “crusty, ill-tempered and usually old man.” Old, huh? A Princeton definition I found on the Internet describes a curmudgeon as a “crusty irascible cantankerous old person full of stubborn ideas.” There’s that “old” again. And, what’s the difference between stubborn ideas and right ideas? That Princeton description also references a “gruff manner” and a “gruff reply.” What’s wrong with that? Many people deserve a gruff reply.
I found a supporter who agrees with my own long-held description of a curmudgeon as someone who is wise, doesn’t like absurd behavior or mediocrity, and uses humor and sarcasm to make his or her point while defusing the other (obviously deranged) point of view. My new Internet friend is Jon Winokur, an author of several books on the subject of curmudgeons, who offers a kinder definition.
First, Mr. Winokur asserts that the maligned curmudgeon has an undeserved reputation for malevolence: “They’re neither warped nor evil at heart. They don’t hate mankind, just mankind’s absurdities. They’re just as sensitive and softhearted as the next guy, but they hide their vulnerability beneath a crust of misanthropy. They ease the
By Don Brown

pain by turning it into humor. They attack maudlinism because it devalues genuine sentiment. Nature, having failed to equip them with a serviceable denial mechanism, has endowed them with astute perception and sly wit.”
Man, I’ve got to meet this guy. He could be my next best friend.
Mr. Winokur continues: “Curmudgeons are mockers and debunkers whose bitterness is a symptom rather then a disease. They can’t compromise their standards and can’t manage the suspension of disbelief necessary for feigned cheerfulness. Their awareness is a curse. Perhaps curmudgeons have gotten a bad rap in the same way that the messenger is blamed for the message: they have the temerity to comment on the human condition without apology. They not only refuse to applaud mediocrity, they howl it down with morose glee. Their versions of the truth unsettle us, and we hold it against them, even though they soften it with humor.”
That’s what I’ve been trying to say for years. He’s just a lot smarter than me. For several years Joshua Manning, the executive editor of our TownCrier, has been calling me a curmudgeon. But I didn’t think he was paying me a compliment. I thought he was insulting me. Remind me to apologize to him.
I don’t mind being a curmudgeon. And, after

being terrified for many years at the prospect of turning 65, I’ve discovered some advantages. There are severe penalties for abusing me. I get a lot of discounts for going to the movies, eating at certain restaurants, shopping at some stores and staying at many hotels. More people call me “sir,” but not as many young people as I would like. My sons call me on a regular basis. I get a Social Security check every month. It doesn’t go very far, but I don’t have to get up very early or work to earn it. If I want to be grouchy, people allow it by chalking it up to an “old” man. I hope I don’t damage my reputation as a pro-
fessional curmudgeon, but I find myself being more tolerant of people’s actions and more forgiving of their goofy ideas. I’m a bit optimistic that they’ll figure out I’m right and see my wisdom. I wonder where I can find an official curmudgeon ID card. And why do most definitions of a curmudgeon use the description “old man?” Aren’t there any female curmudgeons? I’m thinking of organizing a curmudgeon solidarity union (with certification cards) for people to contact when they need clarity about their confused thinking. I can think of a lot of people I would solicit.
Well maybe all is not lost in today’s worldwide economic turmoil. According to news recently released, Disney is going to introduce the revered Disney Channel to Russia in 2009 in a coup that will open a huge new market for the House of Mouse. Western media moguls have been trying to break into Russian TV without much success for a decade or more.
“We believe there is a vast growth to come out of this market despite near-term economic worries,” said Andy Bird, president of Walt Disney International. Once Putin & Company steal enough time away from fomenting various anti-American strategies around the world (i.e.: suddenly sending warships
By Jules W. Rabin

to visit Cuba) and sign off on a finalized deal, Disney will have a sizeable lead over rivals like Viacom. Projected programming for the new channel will include proven winners like Hannah Montana and the indestructible Mickey Mouse Clubhouse Disney also plans to work with Russian television giant Media One Holdings Limited, which currently reaches some 75 percent of the country con-
taining the bulk of its population. Disney will have a 49 percent stake in Media One. The partners also plan to originate programming in Russia. One major thing Disney’s expansionist-oriented executive better concentrate on is making nice with Putin. Based on ever more frequent international communiqués, it appears the Russian prime minister and strongman is becoming more troublesome to deal with for Russia’s “independent” businessmen, as well as foreign companies trying to carve out a niche in the country. Let’s hope before his KGB years, Putin was weaned on Mickey Mouse. Just curious... I wonder how Mickey will play in Siberia.
Members to the Swamp Things 4x4 Club visited Palms West Hospital on Sunday, Dec. 21 to deliver a bit of holiday cheer to pediatric patients. A family-oriented club, the Swamp Things get together for frequent trail rides in the J.W. Corbett Wildlife Management Area. They have also begun doing more community volunteer work. Upcoming projects include a beach cleanup day and cleanup day at Corbett. For more information, visit www.theswampthings4x4club.com or call Gary Specht at (561) 379-9919.
PHOTOS BY CAROL PORTER/TOWN-CRIER

and Gary Specht;
kids
and


a
Entertainment for
PHOTOS BY DENISE FLEISCHMAN/TOWN-CRIER









































By Jason Budjinski Town-Crier Staff Report
DEC. 17 — A Palm Springs man was arrested on multiple drug charges last Wednesday following a traffic stop in Royal Palm Beach. According to a Palm Beach County Sheriff’s Office report, a deputy from the Royal Palm Beach substation was traveling eastbound on Belvedere Road at approximately 4:15 p.m. when he observed a vehicle with an obscured license plate. The deputy initiated a traffic stop and made contact with the driver, 45-year-old Ronnie Dunmore. The deputy asked Dunmore to show him his driver’s license. Dunmore didn’t respond until the second request, and the deputy noticed that he appeared nervous. The deputy asked Dunmore if there were any illegal weapons or drugs inside the vehicle. Dunmore replied that there were not. The deputy then asked for permission to search Dunmore and his vehicle. By this time, a second deputy had arrived. He found a clear plastic baggy containing cocaine stored inside Dunmore’s right shoe. A subsequent search of the vehicle revealed 12.7 grams of oxycodone, 18 grams of Xanax, ten methadone pills and additional cocaine.
DEC. 19 — A traffic stop last Friday in Royal Palm Beach led to the drug arrest of an Acreage man. According to a PBSO report, a deputy from the Royal Palm Beach substation observed 28-year-old Nicholas Raffa run a red light on Okeechobee Blvd. in front of Royal Palm Beach Elementary School. The deputy made a traffic stop and ran a records check on the vehicle, but there was no record of the vehicle identification number. Raffa was arrested for operating an unregistered vehicle. According to the report, a search of the vehicle revealed a cigarettes pack containing one and a half Xanax bars, a plastic straw with a white powdery residue and a blue plastic baggy containing approximately .25 grams of cocaine. The deputy then searched Raffa and found a plastic baggy containing 14 grams of marijuana.
DEC. 19 — A deputy from the PBSO substation in Wellington responded last Friday to the JC Penney store in the Mall at Wellington Green regarding a shoplifter. According to a PBSO report, 18-year-old Rosemarie Winters of Wellington selected several items from the fashion jewelry department, entered the juniors fitting room and exited a short time later. A store security officer then checked the room and found a tag to a necklace, valued at $30. Winters passed all points of sale without paying for the necklace but was apprehended.
DEC. 19 — A resident of Buckland Street called the PBSO substation in Wellington last Friday regarding a vehicle burglary. According to a PBSO report, the victim arrived home at approximately 8 a.m. When she returned to her vehicle at 9:20 a.m., she discovered her Magellan GPS was missing. The vehicle had been left unlocked, according to the report. There was no suspect information at the time of the report.
DEC. 19 — A deputy from the PBSO substation in Wellington was dispatched last Friday to Village Park on Pierson Road in reference to a vandalism incident. According to a PBSO report, sometime between 7:25 and 9:55 p.m. someone smashed the victim’s front passenger window with an unknown object. There were no witnesses or suspects. The case is inactive pending further leads.
DEC. 21 — A resident of Pinto Circle called the PBSO substation in Wellington last Sunday regarding a home burglary. According to a PBSO report, the victim left his home at approximately 5:40 p.m. When he returned at approximately 8:30 p.m., he discovered his Honda pressure washer was missing, along with an electric hedge trimmer, extension cords and a Barbie Cadillac Escalade toy vehicle. According to the report, there were tire marks in the grass from an unknown vehicle. There were no witnesses or suspects reported.
DEC. 21 — A West Palm Beach man was arrested last Sunday on multiple charges following a traffic stop in Royal Palm Beach. According to a PBSO report, a deputy from the Royal Palm Beach substation was traveling westbound on Ponce de Leon Street at approximately 9:30 a.m. when he ran a records check of a 1995 Honda Civic driven by 29-year-old Oscar Mena. The deputy confirmed that Mena’s license had expired. After making contact with Mena, the deputy observed a reduced-size aluminum baseball bat by the side of the driver’s seat. According to the report, the deputy asked Mena if the bat was for protection, and he said it was. A search of the vehicle revealed no other sports equipment. Mena was arrested for the expired license and carrying a concealed weapon.
DEC. 22 — A Royal Palm Beach man was arrested on drug charges Monday in the parking lot of the Victoria Groves clubhouse. According to a PBSO report, a deputy from the Royal Palm Beach substation observed a vehicle occupied by six males backed into a parking space in the otherwise empty parking lot. As the deputy approached the driver’s side of the vehicle, he smelled marijuana emanating from inside. After ordering everyone out of the vehicle, the deputy conducted a search and found marijuana in the center console and in an ashtray. Nineteen-year-old Christopher Kerr admitted to owning the marijuana and was placed under arrest. A records check revealed that he had a warrant for failure to appear in court relating to a traffic charge. He was taken to the Palm Beach County Jail. DEC. 22 — A deputy from the PBSO substation in Wellington was dispatched Monday to a home on Wild Cherry Lane in response to a stolen vehicle. According to a PBSO report, sometime between 2 a.m. and 10 a.m. the victim’s 2000 Honda Civic Si was stolen from his driveway. The vehicle is valued at approximately $8,000. There was no suspect information at the time of the report.

Crime Stoppers of Palm Beach County is asking for the public’s help in finding these wanted fugitives: • Jose Ramirez-Dominguez, a.k.a. Alex Figueroa-Ortiz or Jose Papuco, is a white male, 6’1” tall and weighing 185 lbs., with black hair and brown eyes. His date of birth is 03/18/80. He has a tattoo on his right leg. Ramirez-Dominguez is wanted for violation of probation on a conviction for organized scheme to defraud. His occupation is unknown. His last known address was N. Stuart Circle in Greenacres. Ramirez-Dominguez is wanted as of 12/24/08. • Lashaunta Warthen is a black female, 5’6” tall and weighing 135 lbs., with black hair and brown eyes. Her date of birth is 08/23/88. Warthen is wanted for aggravated assault with a firearm. Her occupation is unknown. Her last known address was Osage Circle in Greenacres. Warthen is wanted as of 12/24/08. Remain anonymous and you may be eligible for up to a $1,000 reward. Call Crime Stoppers at (800) 458-TIPS (8477) or visit www.crimestopperspbc. com.


The clients and staff of the Lord’s Place were the guests of honor at a holiday party presented by Palm Beach County Commissioner Jess Santamaria on Sunday, Dec. 14 at the original Wellington Mall.
More than 200 men, women and children who have been helped out of homelessness by the Lord’s Place, or are currently homeless and are seeking help through the Lord’s Place Engagement Center, were treated to a holiday dinner with all of the trimmings. The commissioner also provided buses to bring the Lord’s Place clients to the event. The Lord’s Place staff and their families were also in attendance.
The Rotary Club of Wellington provided a bag of toys for each child, which they received after a visit with Santa.
A concert of holiday music was provided by Our Lady Queen of the Apostles Catholic Church. Christmas carols were led by Jan Phillips and Sheldon Davis of the Lord’s Place staff.
“We are so grateful to Commissioner Santamaria for his generosity and support of the work of the Lord’s Place,” Executive Director Diana Stanley said. “He sets an example that we should all endeavor to follow. He helped make the holidays special for all of those we serve. We also extend our thanks
to the Rotary Club of Wellington for all they did to help the children of our families at the Lord’s Place.”
The Lord’s Place is a non-sectarian, non-profit organization dedicated to changing the lives of the homeless by providing innovative, compassionate and effective services to men, women and children in our community. Its programs include a family campus in West Palm Beach, a men’s campus in Boynton Beach, the Engagement Center and Cafe Joshua at its Australian Avenue headquarters in West Palm Beach.
For more information, call the Lord’s Place at (561) 494-0125 or visit www.thelordsplace.org.

JessSantamaria’s speechinspiresall



IAMRICH/IAMPOOR.
IAMOLD/IAMYOUNG.
IAMBEAUTIFUL/IAMUGLY.
IAMSTRONG/IAMWEAK.
IAMHEALTHY/IAMSICK. IAMSMART/IAMDUMB. IWORKHARD/IAMLAZY. IAMHAPPY/IAMSAD.
IAMHUMBLE/IAMPROUD. IAMGENEROUS/IAM STINGY. IAMFEARLESS/IAMAFRAID IAMKIND/IAMCRUEL.
IAMSPIRITUAL/IAMMATERIALISTIC. ICANCLIMBANYMOUNTAIN /IWISHIDIDN'THAVETOGETOUTOFBED. ILOVEYOU/IHATEYOU.
ICARE/IDON'TGIVEADAMN. IAMDEMOCRAT./IAMREPUBLICAN. /IAMINDEPENDENT.
IAMCATHOLIC,JEW,BAPTIST,LUTHERAN, METHODIST,EPISCOPALIAN,HINDU, MOSLEM,BUDDHIST,NON-BELIEVER. IAMWHITE,BLACK,BROWN,YELLOW. IAMALLOFTHEABOVE.
IAMYOU/YOUAREME. I AM YOU / YOU ARE ME.


























By Candace Marchsteiner Town-Crier Staff Report
During its December PTA meeting, Elbridge Gale Elementary School held its second annual “Holidays Around the World” potluck dinner. Each family shared a holiday dish representing their cultural heritage. The group held two fundraisers for the Leukemia & Lymphoma Society through a bake sale and a raffle for a Christmas quilt handmade by Suzanne Dowling and Jennifer Ragan, mother and grandmother of second grader Alex Dowling.
The evening’s agenda included second-grade teacher Antonis Loudaros, who thanked the PTA for making possible a trip to the 2008 National K-12 Scholastic Chess Championship in Orlando. Loudaros traveled with eight students, who scored 20 wins. In return, PTA member Karen Holme thanked Loudaros. “We appreciate what you do,” Holme said. “You bring wonderful analytical thinking and mathematical thinking skills to the classroom.”
Throughout the year, Loudaros manages a chess club of nearly 100 students at the school. Additionally, he is holding his own fundraiser to benefit a trust fund for the family of a former co-worker, the late Keely Spinelli, who died of ovarian cancer on Dec. 15. Loudaros, who carried the torch in the past four consecutive summer Olympics, plans to run 600 miles by Feb. 1 and is collecting sponsors per mile.





Students, teachers and administrators from Gove and Equestrian Trails elementary schools have joined efforts to support Air Force Squad Jester 1-4 serving in Iraq.
The project started in October when Squad Leader Michael Josh Humphries, a former student at Gove Elementary, wrote to his mother, Gove Elementary physical education teacher Ellen Smith.
“Hey mom,” he wrote, “just wanted to send some pictures of the kids in our area of operation that we’re trying to help out while we’re here. We bring food and water as often as we can, but they’re in severe need of things we don’t normally have such as school supplies (pens/pencils/ paper mostly), shoes, clothes
and any other amenities, really.”
With the help from students, teachers, administrators in both schools and members of the local community, care packages were sent to Air Force Squad Jester 1-4. Josh’s former teacher Mrs. Henderson and her classes made two batches of cards for the troops. The fifth graders helped package boxes with Gove’s Student Wellness Council, and many teachers donated snacks for packages. Gove teacher Mrs. Rayburn gave money to pay for postage to send 12 packages. Mrs. Lutz’s sixth-grade class sent letters, and the entire sixth grade sent stuffed animals. Eric Stern provided a contact to get goodies, and Glades General Hospital put together a box of 100-plus flip-
flops for the children in Southern Iraq at Camp Bucca.
Equestrian Trails Elementary collected soccer balls, school supplies, packaged and paid for more than 15 boxes of goodies to send to the squad.
“It was a great showing of support, and as Josh’s mom, I want to thank all those who contributed to this worthwhile project,” Ms. Smith said. “There were some teachers who offered to bake homemade cookies or breads, students wrote cards and assembled the packages, community members and local organizations donated goodies to make it all possible.”
For more information about the project, call Ellen Smith at (561) 261-3446.









Seminole Ridge High School is pleased to announce its 2009 Pathfinder Scholarship nominees. The Pathfinder Scholarship, sponsored by the Community Foundation of Palm Beach and Martin Counties, announces its annual winners in May. The scholarship is provided to seniors who have demonstrated outstanding achievement in 18 academic, vocational and athletic categories.
The categories and the nominees are as follows: Academic Excellence, Mark James; Art, Ptah Quammie; Business, Jonathan Monesar; Communications, Andrew Suarez; Community Involvement, Anastasia Bastien; Computer Science, Jessica Garrity; Drama, Shannon Ouellette; Foreign language, Cynthia Torres; Forensics/ Speech, Devon Arnold; History/Political Science, Stephanie MacInnes; Literature, Sarah Grunder; Mathematics, Jordan Hoke; Music, Instrumental, Elizabeth Carmean; Music, Vocal, Devin Tassi; Reach for Excellence, Ashlley Rodriguez; Science, Ramiek Campbell; Sports, Michael Fioramonti; and Technical/Vocational/Agricultural, Lucas Ortiz.
• Football Hawks Chosen
All-Conference — This year’s District 6A football All-Conference team contains many of the Hawk players who thrilled their fans during the season. On first team offense are Jeacky Charles (receiver), Blake Moorehead (guard), Zach Prevatt (tackle) and Tyler Wilhelm (quarterback). On first team defense are Kyle Lager (lineback), Jeff Moise (DB), Shane Shortridge (defensive end) and Daryl Thomas (defensive line). On second team offense are Brandon King (center) and Jordan Schumacher (RB). On second team defense are Woodley Cadet (DB), J.B. Coulter (lineback), Cody Kowalski (lineback) and DeJay Perkins (defensive line). Honorable mention goes to Eric Bernal, Michael Fioramonti, Kyle Irish, Will Jones, Tommy Rodriguez, Twon Roker, Austin Williams and Javian Wrisper. Congratulations, Hawk players!
• ASVAB Assemblies Scheduled — The guidance department has scheduled post-test interpretation assemblies for juniors and seniors who took the ASVAB (Armed Service Vocational Aptitude Battery) in October. The assemblies will be Thursday, Jan. 15 in the auditorium. Students with last names
A-H will attend from 8 to 9 a.m.; last names I-Z, from 9:30 to 10:30 a.m.
• Construction Academy Building Work Progresses — If you walk or drive by the north end of Callery-Judge Stadium, check out the soon-to-be-completed ticket booth/storage building — you’ll easily see how busy the SRHS Construction Academy has been this past semester. Since August, construction academy students have set trusses, sheathed and driedin the roof, hung windows and doors (including a garage door), set in fascia and soffit boards, bent and hung conduit, and installed boxes for fire alarms, electrical systems, and light fixtures.
“People don’t realize how much work and skill go into a building,” academy teacher Mr. Rick Terkovich said. “The kids have really stepped up, worked hard on this, and done a great job.”
The students have had experts in the field teach and guide them. Representatives from Featherston Construction, Preferred Choice Doors and Windows, Broten Garage Doors and Malone Electric have all instructed students this semester.
Poinciana Day School in West Palm Beach recently received honorable mention in the Online Yearbook category of the Lifetouch National Best of the Best Contest.
“While there were many outstanding entries in this year’s Best of the Best contest, Poinciana Day School showed a tremendous amount of creativity and excellence in their yearbook, and we are excited to present them with top honors to encourage them to continue to grow their exceptional program,” Lifetouch Marketing Vice President Bruce Martin said. “Yearbooks are lifelong mementos, and the faculty and students of Poinciana Day School are to be commended for their outstanding work and commitment to a memento that will preserve precious memories for years to come.”
The 2008 yearbook advisor for Poinciana Day School was

Honorable Mention — Poinciana Day School yearbook advisors Tricia Couch of Wellington and Cheryl Scott of West Palm Beach with a copy of the 2008-09 yearbook.
Tricia Couch.
Lifetouch National School Studios is based in Eden Prairie, Minn. Lifetouch has been providing high-quality photography, yearbooks, digital

event books and other printed products to partner schools for more than 70 years. For more information about Lifetouch National School Studios, visit www.lifetouch.com.
Broten Vice President Gregg Davis said his company “believes in giving back to the community, and it’s a real pleasure not only to donate the door but to see kids eager to learn to install it. I didn’t know any school was teaching anything like this, and it’s really great to see students taking on a project like this. It’s been a lot of fun!”
“This building is being done without any school district funds, and there were times when I thought we’d have to stop work because we were almost out of materials,” Terkovich said. “Someone always steps up to help us out. It’s amazing how the community has supported us.”
The academy project is on schedule, and the construction students plan to finish their building completely in April.
• NHS Presents Check to Quantum House — The SRHS National Honor Society recently presented the children’s organization Quantum House with a check for $825, raised by selling “turkey feathers” for a staff competition and collecting change in the “Quarters for Quantum” canisters around campus.


Students at Poinciana Day School have once again have opened their hearts to the community by conducting a toy drive for the holidays. The student council, under the leadership of advisors Tricia Couch and Judi Hildebrandt, both of Wellington, spearheaded the toy drive with the goal of making Christmas brighter for children in need. Students collected new unwrapped toys to help three different concerns.
The student council members, themselves, adopted a threeyear-old boy whose mother has terminal brain cancer. This little boy would not have had a Christmas without the help of others. Student council members collected two large bins of toys of all kinds, including board games, balls and sports gear.
The rest of the toys were taken to Power One Financial Credit Union, which as a major collection point distributed toys

Poinciana Student Council members with a wall of toys.
between the Marine Corps’ Toys for Tots Drive and Voices for Children, who help abused and neglected children in the South Florida area.
Poinciana Day School Student Council President Alicia Hebron of Wellington and Royal Palm Beach, and Vice President Xavier Parris-Turner of
West Palm Beach expressed their desire to help others less fortunate than them.
“We are blessed to have good families and homes and attend a wonderful school,” ParrisTurner said. “As a school, it is important for us to help other people who don’t have those things.”

Mrs. Terri Hills again coordinated Crestwood Middle School’s bi-annual Smiles from Home project, which sent 167 pounds of greetings and goodies to U.S. soldiers in Al Taqaddum, Iraq. The generous spirit of the students and staff was an awesome thing to behold. In these uncertain economic times, the community came together to make the Smiles from Home campaign a resounding success. The unit in Iraq will receive 400 letters, handwritten by Crestwood students, and 167 pounds of festive decorations, goodies and gear.
With many Crestwood Eagles involved in this worthwhile project, a hard job was made less difficult. Not only did all the students in Mrs. Dee Gierlicz’s eighth-grade language arts classes write letters, but the students took on the task of getting 150 individual “goodie bags” sorted and put together.
Crestwood’s own retired media specialist Joyce Rice remembered this project as well. She hauled huge shopping bags and boxes of items that she and her husband’s office staff collected. They even provided $170 toward the expensive bill for a mailing of this size.
Mrs. Laura Miles, a fantastic parent volunteer, spent an entire school day sorting and loading
gift bags for the soldiers, and even ran out to replenish supplies.
Other staff members whose students contributed were Marty Pasquariello, Debbie Still, Kathy Stackhouse, Jacquie Alves, Ginnie Berg, Rosemarie Poggi, Fawn Tenenbaum, Janielle Castillo, Jenna Widness and members of the Grizzly, Falcon and Tiger teams. The school gives a special thanks to Earnie Hills, who hauled all 13 boxes to the post office and filled out the custom forms. What could be even more rewarding than the pleasure of doing for others than a reply from Timothy S. Sanders, CPT, LG, CDR, 528th TC DET (MCT) dated Tuesday, Dec. 9? In his e-mail he writes, “thank you and those great patriotic children at Crestwood Middle School for your great gifts and kindness in your handwritten letters to the troops. My soldiers really appreciate all the nice things that you have given to us while we are overseas, away from family and friends, and serving every one of you with keeping our country safe from terrorism. Your heartfelt gifts and notes of personal encouragement will energize the soldiers to continue to do our jobs and remember what we are here for — all of you.”


The Rev. Dr. Calvin O. Butts III, pastor of the nationally renowned Abyssinian Baptist Church in New York and president of the State University of New York College at Old Westbury, will be the keynote speaker at Palm Beach Community College’s 10th Annual Dr. Martin Luther King Jr. Celebration Breakfast. Themed “Making Dreams a Reality,” the celebration will be held on Jan. 15 at 8 a.m. (complimentary breakfast at 7:30 a.m.). This would have been the 80th birthday of the civil rights pioneer slain at a Memphis hotel in 1968. It falls just five days before the inauguration of the nation’s first African-American
president. The event is free and open to the public. The celebration will be held at the Martin Luther King Jr. Plaza on the Lake Worth campus (4200 Congress Avenue). As part of the event, PBCC will present Martin Luther King Jr. Leadership Awards to two individuals and a local organization that have made significant contributions toward improving the lives of others, particularly the underserved, in Palm Beach County. They include LaToya Ricketts, a Riviera Beach resident who has been instrumental in advocating for the civic, social and educational needs of the community; C. Ron Allen of Delray Beach, who founded the
Knights of Pythagoras Mentoring Network for boys ages seven to 14; and the West Palm Beach Alumnae Chapter of Delta Sigma Theta Sorority, which has been at the forefront of serving the community for 61 years.
Butts took the helm of the prominent 200-year-old church in 1989. It was founded in 1808 when a group of African-American members and Ethiopian merchants, unhappy with the racially segregated seating at the First Baptist Church of New York, withdrew their membership and formed their own church. Past leaders have included the Rev. Adam Clayton Powell Sr. and the Rev. Adam Clay-
Powell Jr., the first black congressman elected in New York.
Butts is one of the founders and chairman of Abyssinian Development Corporation, a non-profit responsible for more than $500 million in housing and commercial development in Harlem. He helped establish the Thurgood Marshall Academy for Learning and Social Change, a public state-of-the-art middle/ high school in Harlem, and Thurgood Marshall Academy Lower School. He became president of SUNY College at Old Westbury in 1999. More information about the event and the honorees is available at www.pbcc.edu/mlk.xml.
Today’s Teen newspaper recently announced its first fiction-writing contest for South Florida teens and the contest winners of its community service essay contest “I Love My Community.”
First-place essay contest winner Teawanna Teal of Inlet Grove High School won two brand new Blitz phones from Personal Communications Devices and Verizon Wireless, valued at $69.99 each. The $50 second-place prize was awarded to Kevin Vallejo of Palm Beach Central High School. Rhode Senat from South Tech Academy won the third-place prize of $25, and Christian Correa of Palm Springs Middle School received an honorable mention.
Contest entries were judged by creative writing professors from Florida Atlantic University and Palm Beach Community College. The essay contest was open to all Palm Beach County teens ages 12 to 19. Those entering were required to answer the following questions:
• What are you doing to improve your community?
• How does volunteering make you feel about yourself?
• Why do you volunteer?
• What organizations are you involved with?
Winning essays will be featured in the January issue of Today’s Teen
Currently, Today’s Teen is running its first fiction-writing contest, which is open to all South Florida teens. Entries will be judged by creative writing professors from FAU, PBCC and Lynn University. The contest theme is wide open, with the intent being to encourage all types of writing. Entries should be between 500 and 2,000 words. Judges will be looking for originality, a well-developed plot and interesting characters. For contest rules, submission guidelines and other pertinent
information, visit www.todays teenonline.com. The first-place prize is FujiFilm’s 10 MP FinePix Z20fd, an ultra-glam digital camera valued at $199.99. Other prizes include an eco-friendly airbag from EastSport and a variety of additional items such as books, CDs, concert tickets and Muvico movie passes. In an effort to raise funds, the non-profit paper also just launched its first two raffles. “Catch Raffle Fever,” is open to adults, and tickets are $50 each. Prizes include restaurant gift certificates, a weekend getaway, an overnight getaway, salon and spa treatments, jewelry and more. The second raffle “For Teens Only” is geared to the paper’s readers. Every single teen entrant will receive a Today’s Teen eco-friendly tote bag and other goodies. Tickets are $15. The grand prize is another FujiFilm digital camera. The paper invites businesses that would like to get involved with a donation of a gift certificate for either raffle to contact publisher@todaysteen online.com.
Today’s Teen, a free, awardwinning monthly paper read by more than 100,000 students, teachers and parents, is published ten times a year and distributed to educators who register to receive the paper directly into their classrooms at middle and high schools in Palm Beach County.
Educators involved in the areas of language arts, reading and other areas enjoy incorporating the paper into their curriculums, but teens read it because it’s written by them for them. The paper welcomes submissions from all teens. To learn about sponsorships, donations or advertising opportunities, or for information about Today’s Teen, call Gwen Cohan at (561) 865-1277 or e-mail publisher@todaysteenonline. com.
• • • Send school news items to: The Town-Crier, 12794 W. Forest Hill Blvd., Suite 31, Wellington, FL 33414. Fax: (561) 793-6090. E-mail: news@goTownCrier.com.












Kinsah is served by a Girl Scout from Troop 673.
recent holiday party. George Morris, a retired Royal Palm Beach village employee, was Santa. Pictures were taken with Santa as each person received their gift. After the gift exchange there was entertainment courte-
sy of retired pianist Bill Fulford, who played and the audience joined in singing old favorites such as “Jingle Bells” and “Rudolph the Red-Nosed Reindeer.” After the program was over, Girl Scout Troop 673 of Loxahatchee served seniors their afternoon meal and holiday cake.


Thanks to the generosity of people who bought trees at the Acreage Christmas Tree Lot, many needy children had a brighter Christmas.
Brenda Pelletier, an adoption advocate specialist who coordinates donations for several charities, picked up five boxes of toys from the Acreage Christmas Tree Lot on Saturday, Dec. 20 for delivery to children in the Foster & Adoptive Families and Head Start programs, she said.
“More children come into care at this time of year. There are families who say, ‘I can’t do it anymore.’ In this economy, I didn’t think I’d get what I got. Without the help in the community, I don’t know what I would do,” she said.
Pelletier, an Acreage resident herself, began her “begging” program nine years ago after adopting her own daughter, 10year-old MacKenzie. “There’s so much need. It doesn’t matter if it’s in The Acreage or anywhere,” she said. “I collect things all year round. Right now, we’re in desperate need of baby items.”
The Acreage Christmas Tree Lot, located on Seminole Pratt Whitney Road, became a giving

Lot.
place when the owners Robert Trepp and Sofia Rossi of Tromsi Inc., Lisa and Jamie Goodhead, and Bobby and Vonnie Maher, decided to ask people buying their trees to donate a toy for Pelletier’s charities.
“We got a lot from people in the community as well as from CBS Radio,” Trepp said. “And we had a whole box of toys from Seminole Ridge High School. It’s a perfect example of when you do things inside your com-
December 2008 was a fun month for the Kiwanis Club of Greenacres and the western communities.
Members held their Dec. 3 meeting at Pine Jog Elementary School, the first “green” school in Palm Beach County and one of the first in Florida. Being green is part of the school’s culture, and the kids love it.
Pine Jog is a unique learning environment on 150 acres of native Florida woodlands and is a national model that shows how the public school system has successfully partnered with other agencies to create an effective and unique learning environment. This model will help students focus on the wonders of science, the beauty of nature and in art.
“Our children must experience nature to understand it, and
eventually they will take part in saving it,” said Pine Jog Principal Fred Barch, a Kiwanis member himself.
On Dec. 13, the club sponsored a lunch with Santa at the Greenacres Community Center, hosting hundreds of children. The club distributed close to 1,000 toys, provided face painting and led arts and crafts activities assisted by Park Vista High School Key Club members.
The L.C. Swain Builders Club and their band furnished music along with K-Kids from Liberty Park and Heritage elementary schools. Food and drinks were provided by Riverside Bank.
To complete December activities, the Kiwanis-sponsored Little League baseball team completed its season victorious and celebrated with an end-of-sea-





son party at the Greenacres Municipal Ballpark that same afternoon. The club meets for lunch on Wednesdays at noon at the Bohemian Garden Restaurant, 5450 Lake Worth Road in Greenacres. For more info., call (561) 214-3413 or visit www. gakiwanis.com.




Santa Claus paid a visit to the Wellington Community Center on Saturday, Dec. 20 to bring toys and cheer to more than 50 local children battling cancer, and their families. The event was sponsored jointly by the Kids Cancer Foundation of South Florida and Little Smiles. Thanks to the generosity of many local benefactors and the overwhelming support of Palm Beach County Fire-Rescue and the Fraternal Order of Leatherheads Society (FOOLS), a festive time was had by all.
Families were treated to a breakfast buffet made possible by Strathmore Bagels and TooJay’s. Everyone had the opportunity to have their picture taken with Santa, decorate Christ-

Airman 1st Class William E. Kriews III has graduated from Air Force basic military training at Lackland Air Force Base in San Antonio, Texas.
During the six weeks of training, Kriews studied the Air Force mission, organization, core values and military customs and courtesies; performed drill and ceremony marches, received physical training, rifle marksmanship, field training exercises and special training in human relations.
In addition, airmen who complete basic training earn credits toward an associate’s in applied science degree through the Community College of the Air Force.
Kriews is the son of William and Sara Kriews of The Acreage and is a 2004 graduate of Southwide Academy in Royal Palm Beach.
mas ornaments and enjoy a morning far removed from the doctor’s office and the hospital. In addition, each family received a gift card and a bag filled with age-appropriate toys for their children.
Little Smiles is a charity that strives to fulfill the needs of children in local hospitals, hospices and shelters with toys, games, videos, computers, outings, special events, limousine transportation, concert and sporting event tickets, specialty dinners and celebrity meet and greets. For more information, visit www.littlesmiles.org or call Michela Green at (561) 3837274.
The Kids Cancer Foundation of South Florida is a charitable
Allison Parssi, a freshman at Wellington High School, can add “internationally published author” to her list of accomplishments. Parssi’s poem “Math Problem” was included in an anthology titled Voices of Everyday Women, published by the Grey Nuns Women’s Wellness Program in Edmonton, Alberta, Canada. The anthology is pub-

and
organization that strives to meet the physical, educational, emotional, financial and spiritual
lished annually ahead of the organization’s Prime Time for Women Conference in Edmonton. An associate of Parssi’s mother who is affiliated with the conference read the poem and recommended she submit it for consideration.
“I was very surprised when I learned they had published my work; and very happy,” said Parssi, who became a nationally published author when the U.S. Fish & Wildlife Service included one of her articles in its newsletter Turtle River Times

Snow was reported on Dec. 12 at St. Peter’s United Methodist Church during their monthly TeamKids event. More than 175 children enjoyed an evening of food, crafts, dancing and playing in five tons of snow. There was also a special appearance by Buddy the Elf! TeamKids takes place the second Friday of each month from 6 to 8 p.m. for children ages three to 11. The cost of $4 and includes a snack supper. For more information, call John Sullivan at (561) 793-5712. (Above) Buddy the Elf (Tom Leinwol) plays in the snow with children.
needs of childhood cancer patients and their families by working with community orga-
Her poetry also has been published in Today’s Teen, a publication of the Palm Beach Post. “We’re very proud of her,” said her mother Jeanette Pomeroy Parssi.

nizations to coordinate and provide supportive care services to patients and their families. For
Navy Seaman Recruit Jordan C. Buss, son of Beverly and Mike Buss of Wellington, recently completed Navy basic training at Recruit Training Command in Great Lakes, Ill.
During the eight-week program, Buss completed a variety of training, which included classroom study and practical instruction on naval customs, first aid, fire fighting, water safety and survival and shipboard and aircraft safety. The capstone event of boot camp is “Battle Stations,” an exercise designed to give recruits skills and confidence succeed in the fleet, galvanizing the basic warrior attributes of sacrifice, dedication, teamwork and endurance in each recruit through the practical application of basic Navy skills and the core values of honor, courage and commitment.

more info., call (561) 586-BABY (2229).

















Patricia Ann Markey, 72, of Greenacres passed away on Friday, Dec. 19. Born in Brooklyn, N.Y. on Sept. 7, 1936, she was the daughter of Herbert and Eleanor Lange.
Pat leaves behind her husband of almost 50 years Bob Markey Sr., sons Bob Markey II of Royal Palm Beach and Brian Markey, and daughter Patricia Bachi of Wellington. Pat is also survived by her daughters-in-law Lynda Eads and Janice Markey, son-inlaw Dan Bachi, and five grandchildren, Daphne Markey, Collin and Devyn Bachi, and Hunter and Sydney Markey.
Pat and Bob Sr. started their life together in 1959 in Brooklyn, moved to and lived in their first house in Uniondale, Long Island in 1960. Following Pat’s parents, the Markeys moved to Sanford, Fla. in 1974. There, Pat continued raising three children and earned a college degree, attending Central Florida colleges and later, Palm Beach Community College, where she received her associate’s degree.
“‘Nanny,’ as our kids called Pat, was the glue that held our extremely close family together,” Bob Markey II said. “She lived her life for us in every way, always putting her family first. Everyone who met her was better off by knowing her. Her extremely unexpected passing has us all unsure of our future. But we know she would be the first to tell us to pull it together and fulfill our lives. And we will try to do that for her.”
In 1977, the Markeys moved to then-remote Wellington. In the 1980s and ’90s, Pat helped Bob Sr. start and build the Town-Crier from a kitchencounter business into one of the most respected and successful community newspa-

Patricia Ann Markey pers. At Bob Sr.’s side, Pat helped form the organization that led to the incorporation of Wellington as a municipality and supported numerous religious, civic and charitable organizations and events. Pat handled accounting, business, human resources, advertising and other chores at the newspapers. Since 1995, she ran the business operations of Palms West Realty, where Bob Sr. is broker and most of the family is associated.
“Mom was the companies’ backbone,” Bob Markey II said. “She could do anything she put her mind to, but considered her job as a mother and grandmother the highlight and priority of her life. In fact, the last thing she did was cheer on her oldest grandson in a high school wrestling match, just after spending quality time on Friday with her other grandchildren.” In lieu of flowers, the family has asked that donations be made to the St. Therese de Lisieux church building fund. For more information, call (561) 310-5629.
The Wellington Women’s Club invites the public to join them for a dinner meeting on Thursday, Jan. 8 at 6:30 p.m. at Binks Forest Golf Club. The speaker will be local media personality and entrepreneur Taylor Morgan.
Daughter of Radio Hall of Fame member Jerry Williams, Morgan founded, owned and operated Sprinkles Ice Cream Shoppe in Palm Beach before leaving to pursue a career in radio broadcasting. In 2006, Morgan branched into television by hosting and co-producing South Florida Dines, which airs on Cable Channel 15. She also launched SouthFloridaDines. com, an online dining guide receiving over 1.5 million hits per month and offering deep discounts on dining gift certificates to over 200 local restaurants. Guest fee for the evening is $30 and includes a full dinner and the program.
To RSVP, contact Mair Armand at (561) 635-0011 or mair @armandpest.com by Jan. 4.
The Caribbean-Americans for Community Involvement will celebrate New Year’s Eve on Wednesday, Dec. 31 at the Royal Palm Beach Cultural Center (151 Civic Center Way). The fun starts at 9 p.m. Tickets cost $45 each, which includes dinner. Entertainment will be by Top Ranking Sound. Make plans to ring out the old and ring in the new in the usual CAFCI classy style. For more information and tickets, call Lawrence Logan (561) 791-0162.
Mentoring 4 Kids is a program of Alpert Jewish Family & Children’s Service. It is a free service for children ages six to 14 being raised in a single parent or guardian home. M4K serves people of all faiths, matching caring adult volunteers with children needing a positive role model in their lives. Most of the children have lost a caregiver through death or divorce. By providing caring adult “pals” of the same gender with similar interests, M4K hopes to provide another positive role model for the child. The volunteer mentor and child build a one-on-one relationship while participating in fun activities for several hours at least twice a month. There is a minimum oneyear commitment to the program. Before any match is made, both the potential volun-
teer and the child and his/her family are thoroughly screened. Following the match, training and ongoing support are provided. M4K is presently looking for children as well as volunteer mentors. For more info., contact Outreach Coordinator Peggy Kroll at (561) 238-0281 or pkroll@jfcsonline.com.
Dance
Feb. 7
Fathers, stepfathers, grandfathers and all blends of family are invited to take part in Wellington’s Annual Father-Daughter Dance on Saturday, Feb. 7. It will be a night of delight designed for dads and their daughters to share dancing, a delicious dinner, games and pictures. Each couple will receive keepsakes to cherish the memories of this fun evening. The event will be most enjoyed by girls between the ages of five and 14. It will be held at the Village Park gymnasium (11700 Pierson Road) from 6 to 9 p.m. Tickets are on sale now and can be purchased at the Village Park gymnasium or the Wellington Community Center. Ticket sales end Friday, Jan. 30 at 9 p.m. and seating is limited, so purchase tickets now before they are sold out. Tickets are $50 per resident couple and $62.50 per non-resident couple. Additional single tickets will be sold at $20 per resident and $25 per non-resident. For more info., call (561) 791-4005. Sponsorship opportunities are still available.
The Wellington Garden Club will meet on Friday, Jan. 9 at the Wellington Community Center (12165 W. Forest Hill Blvd.). The meeting will begin at 11:30 a.m. with a light buffet lunch provided by the members. The business meeting will start at 12:15 p.m., followed by the guest speaker at 1 p.m. The guest speaker will be William H. Reeve IV, president of Botanical Visions in Boca Raton. With 25 years of experience in the South Florida design/ horticultural trade, Reeve is nationally certified in landscape design by the Association of Professional Landscape Designers. As a landscape designer, he has won many awards, served on numerous boards and committees, and has written publications on landscape design and pest management. His topic will be “Using Native Plants in your Landscape.”
Guests are welcome and there is no admission fee. Those who wish to attend as a guest are asked to RSVP to Mary Anne at (561) 968-1062.
Ashley and Joe Maguire, in conjunction with Brenda and Sandy McAdam, hosted an exclusive fundraising event Sunday, Dec. 14 at the invitationonly Wanderers Club at Wellington. The event, which drew more than 100 guests, raised more than $14,000 to benefit the Diabetes Research Institute at the University of Miami Miller School of Medicine.
All guests, mostly from the Aero Club, were “members for the day” at the Wanderers Club and were pampered with a daylong schedule of bliss and indulgence that began with a champagne brunch. A tennis clinic led by Wanderers Club tennis professional Paul Hope preceded a scramble-format golf tournament organized by Golf Director Justin Thompson.
The team of John Carney, Vaughn Kuoppola and Robert
Neuman took first place in the golf tournament, while Mark Plaxen won the longest drive for the men, and Brenda McAdam for the ladies. McAdam also won the closest-to-the-pin contest.
“It was so nice to have the Aero Club residents here today,” Thompson said. “They are neighbors of the course, and the event allowed us to expose them to the facility and the first-rate services we provide. With this event, we were able to have our neighbors and our friends enjoy the facility and benefit a great cause.”
Golf participants experienced the club’s recently redesigned Jacobsen Hardy golf course. The course re-opened in December 2007 and features some of the most beautiful vistas in South Florida as well as some very challenging golf holes.



There are five sets of tees for all playing levels, three practice areas and a driving range that doubles as a polo field.
As “members for the day,” guests received their own lockers in the newly appointed locker rooms and enjoyed the personalized service for which the Wanderers Club is known. Some guests took advantage of the state-of-the art fitness center, while others relaxed by the Olympic-size swimming pool. Families with children also had the opportunity to enjoy the club’s playground and kiddie pool.
Membership Director Samantha Ayers said the Wanderers Club aims to provide an experience that is first class and elegant, yet family oriented. “We want to be a part of the community framework here in Wellington,” she said. “The Wanderers
Club was designed to have something for everyone. It’s for those who golf, or play tennis, and it’s for families with children or without children.”
At the end of the day, an elegant cocktail party and dinner reception on the club veranda provided guests a picture-perfect dining experience. Terri and Carmine Priore III were announced as chairs of a 2010 diabetes benefit in Wellington.
Wellington Mayor Darell Bowen noted that the village is a proud supporter of the Diabetes Research Institute and of the search for a cure for diabetes.
“The diabetes event is always a great event and has strong support from the community,” he said. “Terri and Carmine Priore III are an excellent choice for next year’s chairs — they will do a great job.”
Aero Club Homeowners’ As-



sociation President Bill Thomas expressed thanks to the Wanderers Club for its generosity and excellent treatment. “This was a first-class event, all the way. Between the golfing, the food and the club’s service, it couldn’t have been any better. It was a great day.”
“The Wanderers Club is a magnificent course and facility,” Aero Club resident Mace Horoff said. “It is great to be able to spend time on the course with our friends and our family, and support a worthy cause like DRI at the same time.”
Money was raised for the Diabetes Research Institute through the sale of mulligans for the golf tournament and generous donations. The Diabetes Research Institute is a recognized world leader in cure-focused research, pioneering new cell-based therapies to restore
insulin production. For more information about the Diabetes Research Institute at the University of Miami Miller School of Medicine, visit www.diabetes research.org.
For more about the Wanderers Club at Wellington, call Ayers at (561) 795-3510.






























continued from page 1 staff positions and an $8.7 million reduction in capital spending in the new fiscal year, and another $53 million over five years, in order to offset increases in expenses and shrinking revenues. Among the cancelled capital allocations was $20 million for the village’s park on SR 7. Meanwhile, things were not so grim at budget time in Royal Palm Beach, which has been buoyed to an extent by the sale of its water utility to Palm Beach County two years ago. Royal Palm Beach managed a slight drop in its property tax assessment rate and also only a slight reduction in operating expenditures.
In fact, life seemed sunny enough in the village that last summer the editors of Family Circle magazine named it one of the ten best places to raise a family in the United States — not in any particular region, not in any particular size category, but one of the ten best, period. The magazine lauded Royal Palm Beach for the quality of its schools, its recreational amenities and its environmental outlook, among other criteria.
Not that life in Royal Palm Beach has been completely serene and stress-free — one major cause of angst is traffic congestion, particularly on its clogged main artery Okeechobee Blvd. One story that has made continual headlines throughout 2008 is the confrontation over the county’s planned extension of Roebuck Road from Jog Road out to Royal Palm Beach. The village is taking the county’s side against the City of West Palm Beach, which in turn supports residents of gated communities afraid to find themselves sandwiched between Okeechobee and Roebuck to the north. While West Palm Beach and the opposing residents are claiming love of nature in their arguments against the extension, the county and village point out that the eventual extension was the price agreed to in the 1990s in order to build those communities — on what was then precious wetlands. Funding the extension remained squarely on the county’s drawing board at the close of the year, but the shouting, and the headlines, will undoubtedly continue.
continued from page 1 has to be discussed intelligently.
“I’m not naïve enough to believe there won’t be some infill,” he said. “There’s a lot of development around the existing one since it was constructed. There will be development pressures around.”
If authorities insist on planting a landfill in the Everglades Agricultural Area, Schofield said, there is plenty of space in which to look. “Moving it a mile or two is just not that difficult,” he said. “It’s a huge, huge area. Move it some place that it doesn’t sit right on the main traffic artery leading to the Glades
PBCFR
continued from page 1 respectively, attend Binks Forest.
Sousa said he and his coworkers have seen the challenges many families face during the current recession. He said that the lack of a pay raise for firefighters this year was overshadowed by the fact that so many have lost their jobs recently, and the firefighters wanted to help in some way.
“This is the first year we’ve done this,” Sousa said. “We just feel fortunate to have our jobs now. We like to reach out and touch the local community. We’re headed down to Boca to do another one.” Sousa said firefighters at Station 20 decided on their own to reach out to a Wellington family, although PBCFR often conducts philanthropic activities. Assisting the family in Boca Raton came about through a referral from the United Way.
“The United Way contacted Palm Beach County Fire-Res-
Ironically, Royal Palm Beach clashed with the county over another road project to extend State Road 7 north from Okeechobee. The village supports the road itself, but does not favor a La Mancha connection to it. While RPB eventually assured the county it would not obstruct the work, it nevertheless threw up an actual, physical roadblock — a berm that blocks access from the extension to the La Mancha neighborhood. The move drew the ire of Indian Trail Improvement District officials, who predict the closure of the outlet would send yet more traffic their way.
In Wellington, meanwhile, officials were discussing the future of their own main artery Forest Hill Blvd. in different terms, along the lines of an extreme makeover. The village in late summer began floating plans for a grand redevelopment scheme, dubbed an economic development initiative, that would revitalize some of Wellington’s older neighborhoods and capitalize on strong economic elements already present, such as medical activity centered around Wellington Regional Medical Center and the equestrian economy of the village’s southern reaches. The plan also envisions retrofitting existing aging shopping plazas at the corner of Forest Hill Blvd. and Wellington Trace into an Abacoa-style mixed use development.
One of the several focal points of the “new Wellington” would be a municipal complex for village offices near the present Wellington Community Center. Mayor Bowen suggested that work on the $15 million complex should begin right away to pull the other elements of the plan together. Such a complex is not a new idea, but as with the PBCC proposal, cries of “fiscal irresponsibility” from the opposition soon echoed.
But the concept for the municipal complex has ties to the ugly, headline-making demise of a nascent western communities institution in 2008. The once-promising Cultural Trust of the Palm Beaches cancelled its second annual jazz festival in April and its director Manuel Bornia resigned shortly thereafter. Wellington officials seeking an audit of the cultural organization’s books said the debt-ridden group’s financial records were in disarray or nonexistent.
But the village still hopes to make use of almost $1 million in county funding provided to the trust to build an amphitheater. To do so, the village must
communities. You can do that without appreciably increasing fuel cost or drive time.”
Benacquisto said other area municipalities are opposed to the site adjacent to Southern Blvd. “All the cities oppose that adamantly,” she said. “No city wants that to be the gateway to their community, whether it’s people driving from east to west or west to east… We all oppose it, and I don’t know why it’s continuing to be considered.” Several calls for comment this week to Solid Waste Authority Director Mark Hammond were not returned.
An SWA representative told the Town-Crier on Tuesday that a copy of the special meeting agenda may be obtained after Jan. 1 by writing the Solid Waste Authority, 7501 N. Jog Road, West Palm Beach, FL 33412 or by calling (561) 640-4000, ext. 4210.
cue, and they helped five families at headquarters,” Sousa said. “We had some extra stuff, so they called me to say that they had another family down in Boca. With our overflow of generosity, we’re going to spread it to another family.”
Local firefighters have been busy in the community this season. On Dec. 6, Fire-Rescue employees and members of the Palm Beach County FOOLS (Fraternal Order of Leatherheads Society) used the order’s antique fire engine to deliver Santa to the Royal Palm Beach Wal-Mart, where he greeted children and their families as they did their holiday shopping at the store.
Fire-Rescue and the U.S. Marine Corps ran a one-day
“Stuff the Truck” toy collection at four Toys “R” Us stores in Palm Beach County on Dec. 14. And on Tuesday, the Palm Beach County FOOLS and friends made their fifth annual trip to St. Mary’s Children’s Hospital with Santa Claus and a delivery of toys. Santa and his entourage of elves and helpers delivered toys to all of the children who are currently patients, including some unable to go home for Christmas.
break ground in the first months of 2009 or the money returns from whence it came, and just such an amphitheater figures in preliminary plans for the municipal complex that came off the drawing board in late 2008.
But the Cultural Trust wasn’t the only dream that died hard in Wellington in 2008. By late Oc-
tober, word came down that plans for a long-awaited assisted living facility for seniors would be scrubbed. After years of searching for a site, developer Sunrise Senior Living had inked a deal with the village in February to buy about five acres of that SR 7 park land for about $5 million (money that some
hoped would go toward building a municipal complex). But in the face of a crumbling economy, Sunrise spent the later months of 2008 folding up plans for senior facilities around the nation, and the Wellington project — long sought by local seniors and their advocates — was among the casualties.
Those were some of the top local stories in 2008. And the forecast for 2009 suggests another lively year. Although further economic turbulence is likely, big plans are in the works and old confrontations still simmer. Stick with the Town-Crier in 2009 as we keep you abreast of new developments.
Construction workers from West County Power Partners recently joined representatives from the Palm Beach County Sheriff’s Office District 9 substation in Royal Palm Beach to give out gifts to 20 needy children in Royal Palm Beach. Parents of the children came to the substation on Tuesday afternoon to pick up the gifts for the holiday. Representing West County Power Partners was Miriam Perez, who spoke on behalf of the construction workers. PBSO District 9 Community Outreach Coordinator Diane Smith also spoke.



CityPlace in West Palm Beach held a Hanukkah celebration on Sunday, Dec. 21. Entertainment included singers from the Jewish Community Center preschools in West Palm Beach and Boynton Beach, a group of a dozen teens from Palm Beach County and Israel called the Young Ambassadors, the South Florida group the Shalom Trio, as well as jugglers, magicians and stilt walkers. A collection of local cantors sung the Israeli national anthem “Hatikvah,” while area rabbis joined together to lead the candle lighting. Participating synagogues included Congregation Aitz Chaim, Temple Beth Tikvah, Temple Beth Torah, Temple Beth Zion, Temple Emanuel, Temple Israel, Temple Torah, Temple Shaarei Shalom, Temple Beth David, the New Synagogue of Palm Beach and Temple Beth El. PHOTOS BY CAROL PORTER/TOWN-CRIER


Letters continued from page 4 ning for any other office available? By seating a new council member, we assure continuity. With Margolis, we are at the whim of his whimsy: here today, gone tomorrow. Hey, I heard that there’s a dogcatcher’s job opening in Lake Worth, with no term limits! George Unger Wellington Voters Spoke On PBCC Issue
The voters have spoken; they do not want more taxes even if they are for community colleges. Florida’s Chief Financial Officer Alex Sink has stated that
political leaders are in denial about the dire state of the economy. She went on to say that the state faces a $2 billion shortfall this year. With no economic rebound in sight, Sink has said Florida should consider cutting expenses that are not “mission-critical,” such as $140 million in grants to schools that get A or B grades. The state’s mandated tax cuts have reduced revenue to cities and the state to the point that no programs are safe. Gov. [Charlie] Crist is even considering privatizing Alligator Alley. With money so tight all over the state, where will Palm Beach Community College get the money to build their new campus? They cannot build one building with-


out state funds, yet alone a full campus. Yet in the face of this economy, the Wellington Village Council is going full speed ahead to give away K-Park. They have already spent $100,000 so far on this question. The council wants to even alter their lease agreement by eliminating the $1 million annual payment to the village after 25 years. So, not only are we giving away the land, we will not get any impact fees, we will not get any property taxes, and we will not get any lease revenue. What we will be getting is increased taxes; there is no doubt about that! The answer to our level-ofservice problems, our infrastruc-
ture problems, our capital improvement problems and our tax problems is to keep K-Park; use it partially to build some muchneeded recreational fields, and sell the majority of the acreage to developers who will build our new economic base of a medical arts district that will bring in impact fees, property taxes and high-paying jobs. Which members of our council will step up and vote this proposal down and save Wellington from an economic disaster? Because long after this council has left the building, the residents will still be paying for their decision to give away our land without our vote.

The 18th Annual Children’s Holiday Fishing Classic was held at the Wellington Community Center dock on Saturday, Dec. 20. A record 135 young anglers came out for the event, catching and releasing 205 fish with a total weight of 74 pounds and eight ounces. The biggest fish was a three-pound, two-ounce tilapia caught by nine-yearold Sarah Grossbier of Boynton Beach. The first fish caught was a three-pound, one-ounce tilapia caught by 13-yearold Chase Baruch of West Palm Beach at 9:01 a.m. The most fish caught and released went to Nick Young, with 20. Minnow Division (age 6 and under) — First place: Bellaney Colucci of

Loxahatchee, age four, three fish weighing 1 lb., 5 oz.; second place: Dusting Grobb of Wellington, age five, 13 fish weighing 1 lb., 1 oz.; and third place (tie): Sebastian Edwards of Canal Point, age four, one fish weighing 8 oz., and Gabriel Rodriguez of Wellington, age six, one fish weighing 8 oz. Shiner Division (ages 7-9) — First place: Natalie Rodriguez of Wellington, age seven, three fish weighing 4 lbs., 6 oz.; second place: Sarah Grossbier of Boynton Beach, age nine, three fish weighing 3 lbs., 14 oz.; and third place: Liam Stokes of Wellington, age eight, three fish weighing 3 lbs., 12 oz. Bluegill Division (ages 10-12)



First place: Nicole Linn of Wellington, age 12, five fish weighing 7 lbs., 10 oz.; second place: Lincoln Colucci of Wellington, age 11, five fish weighing three lbs., 8 oz.; and third place: Anthony Boddy of Wellington, age 12, two fish weighing 2 lbs., 15 oz. Lunker Division (ages 13-15)
First place: Chase Baruch of West Palm Beach, age 13, two fish weighing 4 lbs., 3 oz; second place: Jonathan Porra of Loxahatchee, age 14, two fish weighing 2 lbs., 7 oz.; and third place (tie): Candelario Baez of West Palm Beach, age 15, and Joey Campbell of Wellington, age 15, who both caught one fish weighing 1 lb., 12 oz.












































































Well, Christmas 2008 has been reduced to a wad of wrapping paper out on the curb. There are even a few dead fir trees out there already. Three months of excitement and media hype, and now all we’re left with are the bills.
No, that’s not true. Let’s not be so glum. In addition to the bills, there are a lot of ecstatic children playing new video games while high on sugar sprinkles. I don’t know about you, but the kids are the element that makes it all worthwhile.
My only two grandchildren live in Virginia but were in Palm Beach County for just a short while this season. We scheduled a quick rendezvous along State Road 7 — just enough to hand them big boxes (kids like the big boxes) a few days before Christmas. We sat in a restaurant where we easily filled two booths — one with people, one with presents — then took a vote on whether

we should open the gifts right then or wait until the Big Day. It was my idea to have the kids included in the vote even though they were not technically of voting age and — guess what — the vote was wildly in favor of opening the presents right then!
After we’d oohed and ahhed about our gifts, we had to put bows on our heads and take each
other’s pictures... and then my SR 7 Christmas was over.
But the more traditional Dec. 25 holiday was still a few days out. So I kind of adopted the neighborhood children. It’s not like they come over for milk and cookies throughout the year. I just have to buy gifts for kids at Christmastime. I remember getting gifts from distant aunts and friendly neighbors myself when I was a kid, and that was always a joyous thing — an extra present when you least expected it. I guess where kids are concerned, there are no politics involved. Even if there was some sort of family feud going on (and those were rare, thank goodness), my parents never let it interfere with the kids. The kids all got presents from everybody no matter who thought who else was a dunderhead that month. Kids were the Swiss
among the nations that made up the world of my childhood.
It almost made it easier to end some feuds. For instance, a neighbor who didn’t mow their lawn but showed up with presents for the kids was a neighbor who was easy to forgive, or to be loaned a working mower.
In that regard, Christmas and Hanukkah are sort of amnesty days. If a person is feeling guilty about not mowing their lawn but is having trouble swallowing their pride — well, giving a gift to a child is a way to break the ice.
If that advice would’ve helped you out but now you’re grumbling because it came too late, just remember that Valentine’s Day is right around the corner.
And there is no squabble a big box of chocolates can’t solve.
We may soon be witnessing the decline and fall of the NBC empire. The network, famed for shows like Cheers, Cosby, Friends and Seinfeld that dominated the ratings, bringing in millions of viewers and earning a fortune, is withering away.
A week or so ago, it essentially ceded the ten in the evening spot on weekdays to Jay Leno. Unfortunately, the rise of Leno comes not because everyone really wants to see him an hour and a half earlier, but because producing his show would really save a lot of money.
Officially, prime time on television is 22 hours of programming, six nights a week from 8 to 11 p.m. and 7 to 11 p.m. on Sundays. NBC now admits that despite its earnings, despite its connections to so many talented people in Hollywood, 22 hours is too many.
‘I’ On
By Leonard Wechsler

leadership claims that bringing on Leno will allow them to “concentrate on scripted shows,” has few of them around worth watching.
The oft-repeated Law & Order and its spin-offs now comprise most of the drama category. And Law & Order is 20 years old. ER, the last survivor of the network’s famous “must-see TV” Thursday lineups of the 1990s, is wrapping up its run after 15 seasons.
Take away NBC’s Saturday repeats and then take away the four hours of Sunday Night Football and that leaves 15 hours of programming. Then take away the five hours that Leno will occupy. I no longer have to take my shoes off for calculations. There are ten hours left.
Of course, if you take a look at what they show on Friday nights (and if you do, you will be part of a very small crowd), there is not a lot of TV excellence there. Unfortunately, NBC, whose
Actually, its less when you consider that none of the networks do much in the way of original programming on Saturday nights anymore, generally limiting themselves to repeats of some weekly shows, sports and news shows. (Fox does put on a couple of the worst semi-reality shows in the history of television, but it has stuck to news at 10 p.m., so no one should provide a load of praise for their “creativity.”)
Monday nights feature Chuck and Heroes, probably the closest things NBC has to hit shows. My Own Worst Enemy has already been cancelled. Life has its interesting moments, but mainly because it is Law & Order with quirky characters.
Yes, there are some good comedies on Thursday evening. But that about does it for comedy until Leno shows up. When a network has to provide hours of Deal or No Deal as filler as well as embarrassing people into losing weight in The Biggest Loser, they really have no place to go.
Who will benefit from NBC dropping five more hours of programming? Well, the network gets a show that may not cost more than Deal or No
Deal. They can sell five hours worth of advertising for a show that will cost less than one episode of ER. CBS and ABC will both come out ahead in some ways because they will have less competition. Ratings will go up for their shows... and that may save some worthwhile series. Even viewers may come out ahead. There is not a real lot of comedy around on prime time television. CBS has Monday night, NBC Thursday. ABC sort of slips a few comedies in here or there. So if Leno stays as funny as he has over the past couple of decades, the new show does provide a place to go.
But if giving up major portions of
Last week my wife Sharon and I hosted our annual holiday party for our family. I thought that because of the economy, we wouldn’t have a holiday party this year. Wrong. My wife would not even entertain that idea. My next thought was to have a very low-key holiday party. My wife almost liked the idea, but of course I was wrong again. (I finally found out something I am very good at: being wrong.)
Usually at this time of the year my garage looks like a Toys “R” Us warehouse. This year, of course, that didn’t change.
The only thing my wife did different this year was to ask my grandkids what they wanted for the holidays. Most of my grandkids take after my wife. Each one wanted something that was kind of expensive… OK, very expensive. And being the kind of grandmother my wife is, she went out and bought each kid exactly what he or she asked for. I wonder why she never gives me exactly what

By Ernie Zimmerman

I want. I guess that is another story for another time. I don’t think there is a store in the western communities that did not benefit from my wife’s shopping spree. To her credit, she was done with all of her shopping the day after Thanksgiving. In my wife’s mind, as long as there are stores open, times are good enough to spend my money. She told me she never saw such good prices as she did this year. She said it was almost like the
stores were paying her to come into their stores.
Once again I tried to explain Economics 101 to my wife, but just as in past years, it was a total waste of time.
At the party, the kids were very excited. When it came time to open the presents, they were all very happy. And why shouldn’t they be happy?
Each kid got exactly what he or she wanted. I would be happy too if I was in their shoes.
One of my twin grandsons, Chandler, got a remote-control boat. I don’t have a body of water near my house, so for more than an hour he was playing with the boat in my pool. OK, I was playing with the boat also.
My share of the spending pie was not that great.
One of my sons gave me a DVD player for the TV in my bedroom. I will now be spending more time in bed awake rather asleep. My other son gave me a couple dozen pairs of socks I can wear on my daily walk.
Eventually the time came for me to open the present my wife gave me. I must admit it was wrapped very nice. I was starting to wonder what my gift could be. The gift caught me off guard. In my wildest dreams I would never have imagined the thing my wife picked out for me. It was a stuffed animal. It even had a name. I am now the proud owner of “Charlie the Singing Cow” (I kid you not). Perhaps Charlie resided in the dollar store before he was rescued and brought to my house. Charlie is as cute as any cow I have ever seen. Maybe next year I will give my wife a stuffed animal instead of gold. When you squeeze one of Charlie’s legs, he starts singing his one and only song, “Don’t Worry, Be Happy.” So I decided to take Charlie’s advice and not complain about all the money that was spent on the party. I will “be happy.” I wish everyone a happy and healthy holiday season. And don’t forget, “be happy.”













































Friends of the Okeeheelee Nature Center presented a winter holiday party on Friday, Dec. 12 at the nature center. During the event, volunteers received certificates of appreciation and Palm Beach Zoo President and CEO Dr. Terry Maple spoke to the guests about his vision for conservation and improvements for the zoo. (Above) Maple signs books for Virginia Bowen. (Below) Volunteers display their certificates of appreciation.
BY DENISE FLEISCHMAN/TOWN-CRIER

Ballet Florida’s 23rd season features: The Nutcracker, Cinderella and A Midsummer’s Night Dream.
Ballet Florida is the resident professional dance company of one of the most opulent and cultured areas in the world — Palm Beach. Established in 1986 by artistic visionary Marie Hale, Ballet Florida consistently earns international recognition for its achievements in both classical and contemporary dance. Committed to bringing new works to the stage, Ballet Florida regularly performs world premieres by the most celebrated choreographers of the day.
Ballet Florida makes its home in West Palm Beach and is a cornerstone of CityPlace, the symbol of downtown’s growing cultural and economic revitalization. The Ballet Florida EllisVeselsky-White building contains state-of-the-art studios, rehearsal spaces and classrooms, as well as staff offices, conference facilities and ticket offices. The Academy of Ballet Florida offers unparalleled dance training to hundreds of adults and children. Ballet Florida continues to expand its outreach to special populations through its City Dance Outreach Program that provides dance training and full scholarships to children from inner-city schools. This season’s performances include:
• The Nutcracker — Hale’s The Nutcracker is recognized as South Florida’s most spectacular holiday family event for its dazzling sets and costumes and breathtaking special effects and dancing. Nine performances will be held at the Kravis Center for the Performing Arts from Dec. 23-28, plus a special performance for special-needs children and adults. The Nutcracker is, in our opinion, one of the traditional starts of the Palm Beach cultural season! The story is over 150 years old and tells of the magician Herr Drosselmeyer whose nephew has been imprisoned as a small nutcracker doll by the wicked Queen of the Mice. For the spell to be broken, the King of the Mice must be killed and a beautiful girl must fall in love with the Nutcracker despite his ugly appearance. Following a Christmas party at her home, Drosselmeyer takes his goddaughter Clara into a world of magic and illusion, where she helps him free his nephew. As a reward, Drosselmeyer takes Clara through the Land of Snow to the Land of the Sugar Plum Fairy. There, wonderful entertainments are arranged. As the illusions end, Drosselmeyer finds that the spell has truly been broken. The audience, young and old, remains forever enchanted. The Nutcracker runs Dec. 27 at 1 and 7 p.m., and Dec. 28 at 1 p.m. at the Kravis Center (701 Okeechobee Blvd., West Palm Beach). Tickets cost $20 to $75.
• A Midsummer Night’s
Dream (Kravis Program I ’09)
— This most popular Shakespearean tale is retold with exquisite grace and artistry through Norbert Vesak’s choreography. Follow the story of the lovers as they stumble through the kingdom of the mischievous fairy king and queen. This is still the only place to see a donkey dance! Easily understood by both children and adults, this is the perfect “first ballet” experience. Runs Jan. 30 at 8 p.m. and Jan. 31 at 2 and 8 p.m. at the Kravis Center. Tickets cost $20 to $75.
• Cinderella (Kravis Program II ’09) — The original “rags to riches” story is told through the magical setting of Ballet Florida’s dancers and Vicente Nebrada’s choreography. Watch as the original dysfunctional family evolves into the princess fairy tale. The ultimate “happily ever after” story runs March 6 at 8 p.m. and March 7 at 2 and 8 p.m. at the Kravis Center. Tickets cost $20 to $75.
• Duncan Program II ’09
(Mixed Bill) — A mixed bill of four ballets to delight the senses: Smile With My Heart tells three stories of love with a scintillating score of familiar Rogers and Hart songs. Coeur de Basque is modern yet rooted in classical dance. Baker’s Dozen is a signature work from the legendary Twyla Tharp — lyrical, lighthearted and fun. Read My Hips is an explosive work that jumps off the stage and confronts the audience in their seats. This runs April 24 at 2 p.m. and April 25 at 2 p.m. and 8 p.m. at the Duncan Theatre at Palm Beach Community College in Lake Worth. Tickets cost $30 to $40.
• Eissey Program II ’09
(Mixed Bill) — The season ends with a flourish of three performances: Bartok Concerto is a wonderful fusion of ballet styles bringing all the traditions of the Royal Ballet in London and adapting them to a very American way of dancing. Dvorak Serenade begins with a moody, dark opening and surprises with its fun, frivolous appeal. Our Waltzes is a combination of elements from the Viennese school with the spirit of Venezuelan music — a romantic dance with temperament. The program runs May 1 at 8 p.m., May 2 at 2 and 8 p.m., and May 3 at 2 p.m. at the Eissey Campus Theatre at Palm Beach Community College in Palm Beach Gardens. Tickets cost $30 to $40. Join us at the theater as Ballet Florida dancers, costumes and sets take you to the magical world of ballet. For more information or tickets, visit www. balletflorida.com or call (561) 659-2000
Joe & Kathryn, the Phantoms, are featured writers for the Town-Crier newspaper and www.yournews.com. Comments are welcome at thephantom diners@aol.com.






























By Paul Gaba Town-Crier Staff Report
In a battle of three-pointers, free throws, turnovers and tenacious defense, the Royal Palm Beach High School girls varsity basketball team made more of its opportunities down the stretch… and that was all the difference.
The Wildcats spread the wealth as part of a 13-3 closing run in the final 3:52, including hitting six free throws over the final 1:25 to give Royal Palm Beach a 47-37 home court victory over Palm Beach Central High School on Thursday, Dec. 18.
The defeat was Palm Beach Central’s first of the season, following nine consecutive victories. The Broncos (9-1 overall, 3-1 conference) and Royal Palm Beach (8-2, 4-1) meet again at Palm Beach Central on Jan. 22. Royal Palm Beach saw Ikeria Corbett, Amber Ford, Patrice Collie and Mariel Medina each contribute offensively down the stretch. The final fury began when Corbett created a turnover and found Ford wide open for a breakaway lay-up with less than four minutes remaining in regulation time, giving the Wildcats a 36-34 lead.
After Broncos guard Sharnele Brown and Corbett traded free throws, Collie and Palm Beach Central’s Porsche Shakes swapped field goals, making the score 39-37 in favor of the host Wildcats. Palm Beach Central’s Diamond Jones missed a three-point attempt, and Royal Palm Beach responded with a bucket by Medina, to boost the lead to 41-37 with 1:25 left.
After that, it was all Royal Palm Beach from the free-throw line. But the

stretch run was marred by two inci-
dents. First, with 38 seconds left, Ford was fouled by Shakes, who landed awkwardly during the play and apparently injured her right leg. After Shakes was helped off the court, Ford coolly sank two shots.
Corbett was intentionally fouled 12 seconds later and hit her free throw.
After getting the ball back following the free shot, Ford was fouled and sank a penalty shot, and Corbett wrapped up the scoring with a pair from the line with eight seconds remaining.
The 37-point score was Palm Beach Central’s lowest of the season; their previous low was in a 53-33 victory over Suncoast on Nov. 20.
Given how both teams entered the final quarter — and how they responded from the free-throw line the first four minutes of that final stanza — many might have been surprised that it was Royal Palm Beach that converted from the stripe down the stretch.
Due to a plethora of Wildcats fouls, Palm Beach Central entered the fourth quarter already in the double bonus, meaning the Broncos were guaranteed free throws every time a player was fouled.
At the same time, Palm Beach Central had been stingy when fouling Royal Palm Beach. In addition, with the game tied at 32-32 with 5:30 remaining, the RPB’s Collie missed four consecutive free throws in a 15-second period.
“That’s not like Patrice; she is one of my best free-throw shooters,” Head Coach Anthony Dangerfield said. “If she knocks those shots down, we’re playing up by four. But gratefully my team took it from a standpoint that, ‘if
we don’t score, they don’t score.’ We just relied on our defense to create a scoring opportunity, like it did with Ikeria finding Amber for a open lay-up.”
Neither team was overly successful from the charity stripe. Palm Beach Central hit eight of 18 for the game, while Royal Palm Beach converted on 14 of its 25 attempts.
The game opened up with Palm Beach Central on fire. The Broncos took a quick 5-0 lead on a basket by Jones and a triple by Brown. After Royal Palm Beach drew within one, Palm Beach Central scored the final three points of the first quarter, making it 84 after eight minutes of play.
During the first quarter, both teams played tight defense. But entering the second quarter, Royal Palm Beach turned up the defensive pressure, going on a 6-0 run over a nearly sixminute stretch to take its first lead of the game. Three Wildcats — Ford, Latoya Harvin and Collie — each drilled buckets to help take the lead, 108.
After Palm Beach Central regained the lead (14-13) off a Lexus Love basket, Medina sank a three-pointer with 13 seconds left to give the Wildcats a 16-14 halftime lead.
Royal Palm Beach scored the first seven points of the second half, capped by another Medina triple, to give the Wildcats a 23-14 lead with 6:46 left in the third quarter. But Palm Beach Central fought back, using a 9-2 run covering the end of the third quarter and start of the fourth, to tie the game 32-32 with 6:18 remaining. The run included a desperation threepointer by Amanda Collins, who con-

nected from behind the arc while falling backward with 19 seconds left in the third quarter.
Palm Beach Central missed a golden opportunity to add to its run when Jones missed a pair of free throws with a mere tenth of a second left in the third quarter. “The key to our victory, I would say, would be us settling down both offensively and defensively,” Dangerfield said. “As we continued attacking the basket, we created better shot opportunities for ourselves.”
Palm Beach Central’s Brown led all scorers with 15 points. Royal Palm Beach’s scoring was paced by Ford and
Medina, who tallied 11 points each. Medina did most of her damage from long distance, hitting three three-pointers in the game. “She is very dangerous. She kind of got off to a slow start to begin the season, but as of late she’s been shooting the ball very well,” Dangerfield said. “As for the balanced attack, by no means was it an aberration; it is something that we have been working on during practice, as far as spreading the ball around.”
Royal Palm Beach is in action this weekend at the Fort Myers Holiday Tournament, while Palm Beach Central attends the KSA Disney Invitational Dec. 27-30.


By Paul Gaba
Town-Crier Staff Report
Coach Scott O’Hara is the eternal optimist and team player. He is working hard to instill these traits in the Seminole Ridge High School girls basketball program.
“Our philosophy is that a true team should be better than a group of individuals,” O’Hara said. “A measure of success for us would be for each player to say that she is a better person and player for being on our team.”
A quick glance at the Hawks’ 3-9 record does not show the gains made thus far in the season. Seminole Ridge lost seven games before defeating John I. Leonard on Dec. 5, then lost two more. But SRHS has won its past two contests, knocking off Centennial and Berean Christian.
“Our biggest strength is our depth and our never-say-die attitude,” O’Hara said. “This comes from our hard work ethic. We have improved from last year
with our teamwork, shooting and defense. For the first time, we have depth where we can take out a starter and put in another girl. We’re pretty compatible there. We can put in players from the bench and not be hurt as much as we were in the past.”
The Hawks have two seniors in their starting rotation, flanked by a pair of juniors and a sophomore. Senior cocaptains Charleen Briette and Bobbi Imbimbo bring much-needed experience to an up-and-coming program that finished 8-16 last season.
Briette has been a member of the varsity Hawks for four years, and leads the team with 12 points a game. One of the advantages she brings to Seminole Ridge is her experience not just with the team, but with summer travel league play.
“That makes her an exception on our team,” O’Hara said. “The other girls look up to her because she’s played so much basketball; she’s polished and
experienced. She’s a leader, and she really sets us up offensively and defensively.”
With no girls basketball recreational program in place in the Acreage/ Loxahatchee area, Briette is a rarity when it comes to hardwood experience, O’Hara said. This is one area where SRHS has trouble matching up against power programs such as Palm Beach Gardens and Palm Beach Lakes.
Imbimbo gives Seminole Ridge a presence under the basket. “She’s a very strong rebounder, and while she’s not a big scorer, she will get garbage points under the hoop, because she works so hard,” O’Hara said. “She does a solid job boxing out for us, and she hustles on the court. She gets a lot of hard work points, and she’s not afraid to fight for the ball.”
Juniors Isabel Valencia and Amanda Eden further emulate their coach’s philosophy. Valencia, the team’s outside threat with 13 three-point field goals
so far, is “a tough, gritty, hard-nosed player; we nicknamed her ‘the warrior’ because she never gives up,” O’Hara said. “She can be hurt or sick, but she will come and play.”
O’Hara called Eden “a coach’s dream because she comes to practice every day wanting to get better. She pushes herself, which is nice to see. She’s one of those girls who refuses to give up, has a very positive attitude and is always competing.”
The fifth starter is sophomore Deidre White. O’Hara described her as “a very athletic player, and what she lacks in experience, she makes up for with athleticism. She hustles all over the court.”
The Hawks are building through a younger, stronger, balanced bench. It includes freshmen Katie Macomber and Bianca Lagos, sophomores Rebecca Lane and Shayla Tyler, juniors Shannon Greeley and Miriam Burow, and seniors Shaniece Spen-
cer and Deanna Ramcharan. Of his seniors off the bench, O’Hara said Spencer is “very athletic, and can play either the forward or guard positions, which is invaluable. She is an excellent dribbler and rebounder.” Ramcharan “is an excellent shooter, and a role model for the rest of her teammates,” O’Hara said. “She’s the type of kid you root for and want to see her do well. You hope your own daughter grows up to be like she is.” Greeley is in her third year of being coached by O’Hara. Like Spencer, Greeley can play multiple positions. In addition, O’Hara described her as a “very smart player who doesn’t make mistakes. She is a good rebounder and shooter.”
Burow is a first-year varsity member who “has shown great improvement with ball handling skills,” O’Hara said.
Tyler missed a portion of the season
See HAWKS, page 33
It was love at first sight.
David Tonneson’s trainer had set up an appointment for him to try a sale horse. Tonneson drove from his home in Hamilton, Mass. to Vermont to see what his trainer had described as the perfect horse: Wood Fox, a five-year-old, 16.3-hand bay Thoroughbred-Oldenburg cross, very bold and brave.
Kelli Temple was working with the horse. She remarked that she was going to be fussy about who ended up with “Woody,” because he was such a special horse. She proceeded to ride him on the flat and over jumps, then offered to let Tonneson try him.
“I flatted him, then I dismounted,” Tonneson said. “Kelli asked if I wanted to jump him, and I said no, I could see he’s a wonderful jumper.” He didn’t tell Temple that he couldn’t jump Wood Fox, because he’d never jumped a horse in his life! He’d only just started riding the previous year, at age 56, and planned to show in three-day eventing. These shows involve three days of com-

By Ellen Rosenberg

petition: dressage, stadium jumping and crosscountry jumping.
“I was afraid if I told her I couldn’t jump, she wouldn’t sell me the horse,” Tonneson said. “I’d already fallen in love with him. It was purely physical, like falling in love with a woman. She took him out of the stall, and all I could think was, ‘oh my god.’ He was my horse at that moment.”
Tonneson bought him then and there. That was September 1991. The previous year, he had been invited to watch the cross-country portion of a meet with his friend Michael Plumb, a legendary eventer inducted into the U.S. Olympic Hall of Fame this year.
“I was fascinated by eventing,” Tonneson said. “I loved the risk of it, the way the horse and rider had to work as a team. Unlike other jumping sports, in cross-country, you can’t even see the first jump from the start box. You’re galloping up and down hills, through woods and water, out in the open, and every course and terrain is different.”
Six months after buying Wood Fox, Tonneson began competing. When he’d been riding for about five years, he was invited to the selection trials for the New England states for the championship in Gladstone, New Jersey. The team placed second.
Woody retired at 14 in 2000, but he never stopped working. Tonneson’s 13-year-old granddaughter Jessica rode him and won in hunter paces, charging happily over three-and-a-half-foot stone walls and galloping over ditches. Even now, at 22, Woody is ridden four times a week and ponies young horses.
Tonneson moved to Wellington in 2001 and stabled Wood Fox next to his house. His neighbor Lois had a horse named Sean that she was afraid to canter. For three years, Tonneson watched as trainer after trainer worked with Lois and her horse. Sometimes it was so bad he couldn’t stand to watch anymore.
One day, he glanced over the hedges and noticed yet another new trainer riding Sean and moving the horse in a way he’d not seen before. The following week, he saw her riding Sean again. The unknown rider turned up again the following week, and Tonneson had to find out who she was. He had a young horse that needed training, and this woman was good.
Tonneson walked into Lois’s ring just as the trainer had gotten her up onto Sean. Tonneson waited quietly and watched, with admiration, as the trainer gave Lois enough courage to finally ride and canter her horse for the first time. When she had successfully ridden Sean, Tonneson walked over and told her, “Lois, I’m so happy for you.”
The trainer, whose name was Gabrielle Provaas, was startled. This strange man had just appeared out of a hedge. But she was also impressed.
“I immediately liked that this man was so happy for someone else, and there was no benefit in it for him,” Provaas said. “Then he said that he had a horse that needed training, and
asked me to help. That’s how we met. It was a beautiful way to start a relationship.”
The relationship started with horses and deepened from there. “God had his hand on our shoulders and pushed us together,” Provaas said. “We’ve both been in places where almost everything was taken away from us. We both appreciate each day and each thing. We love every day God gives us.”
Provaas, too, is involved in three-day eventing, and both she and Tonneson also show jumpers at the Winter Equestrian Festival. Provaas is working with Junior, a young open jumper, and Tonneson placed in the top three at WEF in Adult Jumpers.
“There’s nothing more exciting than galloping cross country, seeing those two ears forward in front of you,” Provaas said. “The horses love it. They eat up the jumps. It’s the ultimate thrill of being together with a horse.” Tonneson recalls something Temple told him years ago: don’t focus on the day, just enjoy the process.
“I didn’t know what she meant then,” Tonneson said. “I do now. When you focus on the day, you’re thinking about how well you placed in this particular class in this particular show. But that’s not what’s really important. You should be focusing on building the teamwork and the relationship with your horse. It’s not about how you did against the other riders, whether you placed first or 23rd. It’s about the process of improving yourself, personal improvement. It’s where you are now, as opposed to where you were on the way to where you’ll be. I’m a very lucky man.” And Provaas, too. That never would have happened without Wood Fox. Love at first sight.
By Candace Marchsteiner Town-Crier Staff Report
The Wellington High School boys basketball team held a winter break camp for kids on Saturday, Dec. 20. Volunteer players and the coaching staff drilled the young athletes in shooting, passing, ball handling, defensive maneuvers and rebounding skills.
BY
“We want to provide an atmosphere where kids can learn and have fun doing it,” Head Coach Matt Colin said. “Hopefully they’ll walk away with drills to make themselves better basketball players.”
The next camp will be held in June 2009. Proceeds from the $30, four-hour camp benefit the Wolverine basketball program.








The Royal Palm Bassmasters held their end-of-year tournament Dec. 13 and 14 on the Lake Osborne waterways. First place was awarded to the team of Mike O’Connor (boater) with nine fish weighing 20 lbs., 7 oz. and a draw weight of 4 lbs., 13 oz. for a total team weight of 25 lbs., 4 oz. Second place went to Mike Gershberg (boater) with 10 fish weighing 17 lbs., 14 oz. and a draw weight of 4 lbs., 13 oz. for a total team weight of 22 lbs., 11 oz. Third place went to Ed Singleton (boater) with nine fish weighing 12 lbs., 10 oz. and partner Jeff Helms (non-boater) with one fish weighing 9 lbs., 4 oz. for a total team weight of 21 lbs., 14 oz. The Big Fish winner and “Calcutta” for Saturday was Jeff Helms with a fish weighing 9 lbs., 4 oz. The Big Fish winner and “Calcutta” for Sunday was Ed Singleton with a fish weighing 2 lbs., 10 oz. The Lunker Fund was paid out to Helms for his bass weighing 9 lbs., 4 oz. Bassmasters meetings are held on the second Thursday of each month at the Royal Palm Beach Recreation Center. Tournaments are held the following Sunday. Dues are $25 a year; tournament entry fees are $30 per person. For more info., call Irene at (561) 793-7081.



Wellington Tennis Center held its Junior Holiday Festival on Dec. 18. The event featured games, prize courts, matches, contests and a pizza party. More than 40 kids participated in the activities. The Junior program will start up again Jan. 5. For more information, call the Tennis Pro Shop at the Wellington Community Center at (561) 791-4775. Pictured above are the young tennis players on the court.



From Dec. 19 to Dec. 23, Wellington Village Park hosted hundreds of soccer teams playing in the annual Adidas Palm Beach Classic. Wellington High School’s varsity teams were two of the participants in the tournament looking to gain state recognition.
With its unbeaten season on the line, the boys team got a firsthand look at possible state playoff opponents. Facing Coconut Creek, Cocoa Beach and Lyman high schools, the Wolverines finished in first place with a perfect 3-0 record.
In the team’s opening game, seniors Ricky Zamora and Andrew DiLallo led the surging Wolverines over Coconut Creek High School. A hat trick from Zamora was more than enough as the Wolverines won 5-0.
Sophomore Kamil Balcerzak and DiLallo also scored.
To put it mildly, the game with Cocoa Beach was a bit more physical. Junior Brandon Servellon got the Wolverines rolling on a goal early in the game. From that point on, WHS did not look back. After Zamora scored to make the game 3-0, his celebratory behavior caused him to receive two yellow cards and a game ejection. Cocoa Beach retaliated five minutes later when they knocked down WHS senior Andres Londono. Wolverine Head Coach Mike Aaronson played the situation smartly when he took out most of his starters shortly afterward. Sophomore Nick Brewer put the
By Josh Hyber

game away with a goal that made it 5-0.
In the championship game, the Wolverines took on state rival Lyman High School. In a rematch of numerous state playoff games from years past, WHS and Lyman needed penalty kicks to decide the victor.
DiLallo and Felipe Carbonell both had scoring chances in the first half but weren’t able to capitalize. Eventually, in the second half, Londono scored on an awkward deflection. The wellearned goal gave the Wolverines a 1-0 lead. However, with just seconds remaining in the game, Lyman shot a ball that cleared WHS goalkeeper Aaron Dupere to tie it 1-1.
In penalty kicks, Londono, senior Kojo Thompson and junior Max Zoete scored past the Lyman goalkeeper. With a 3-2 advantage and needing a save to win, Dupere made a lunging dive to his right, turning the ball away. Fans and teammates stormed Dupere as a massive pile formed in the center of the field. A wild celebration took place as WHS took home the first-place trophy. The tournament championship improved the Wolverines record to an impressive 14-0-1.
Wellington Roller Hockey League’s Player of the Week is seven-year-old Teddy Miloch, the Training Division Lightning’s forward and goalie.
Miloch’s favorite professional hockey team is the Tampa Bay Lightning, and his favorite professional hockey player is Sidney Crosby.
Other favorites of Miloch include his favorite bands, the Jonas Brothers and Disturbed; TV show, The Suite Life of Zack & Cody ; video game, Wii Fit Snowboarding; and his favorite food, double hamburgers. A little known fact about Miloch is that he recently joined the Cardinals in the Wellington Football Association and helped his team win the Super Bowl.
Miloch started playing roller hockey with the WRHA at the age of four. He is also currently an assistant coach for the WRHA Mighty Tyke division,
continued from page 31 due to a back injury, but will be back in action when the Hawks take on their January schedule.
Lane, the team’s second-leading rebounder, was varsity as a freshman. She, Tyler and current freshmen Macomber (the team’s tallest player) and Lagos (back in action after an ankle injury forced her to miss three weeks), offer glimpses of the future, O’Hara said.
“We didn’t have a lot of depth in the past, but when we have freshmen who have played before, they can step up on the

in which his brother Josh plays. Miloch has developed a passion for both hockey and football and has a great work ethic. The Village of Wellington is currently accepting roller hockey registration for the upcoming season, which will begin Jan. 21. Call Wally at (561) 252-5478 for more information.
varsity team,” O’Hara said. “The future is bright because we have so many good young players stepping up and helping out this year.”
O’Hara said his team is looking to improve in the second half of the season and make a statement.
“Our biggest challenge is to compete every game, regardless of the opponent, and to improve after each practice and game,” he said. “Our opponents are all good teams, especially those teams in our district.”
Seminole Ridge’s district competition is rock-solid. Palm Beach Central stands at 9-1, while Royal Palm Beach and Palm Beach Gardens each post an 8-2 record. Palm Beach Lakes is 7-1.

Girls Soccer — Also taking part in the Adidas Classic, the WHS girls soccer team held its own against some of the state’s fiercest female competition. With senior defender Ari Barletta out of the lineup, Head Coach Fern Brewer was forced to make several lineup adjustments. Surprisingly, sophomore forward Natalie Puñal, who leads the team in goals, started two games on the bench. Instead, freshman Brittany Middlebrook, who more often than not starts at midfield, played Puñal’s forward position. Sophomore Chelsea McCaulley took Middlebrook’s vacant midfield spot, and senior Ashlii Smith, who normally plays forward, started on defense for Barletta.
“Hopefully I’ll still start when Ari comes back, but I feel I belong out there,” McCaulley said.
WHS opened its play with state powerhouse St. Thomas Aquinas. The lineup changes did not click right away. Just nine minutes into the match, the




Raiders found a hole in the Wolverine defense and shot a ball past WHS goalkeeper Sam Bandremer. The Raiders scored another goal to make the score 20 before the half concluded.
St. Thomas continued to pick the Wolverines apart in the second half with precise passes and high-speed rushes. However, due to spectacular play from Bandremer, they could not gain advantage on them. To cope with the fast pace, Brewer rotated a mix of players at a few positions. Sophomore Melissa Welch and freshmen Katie Casey and Alexis Jurado rotated between forward and midfield. Jurado put the Wolverines on the board just before the 20-minute mark on a pass from Puñal. The game ended this way, and the Wolverines were 0-1 for the tournament.
Wellington’s next match was against Merritt Island High School. Puñal, who yet again came into the game as a reserve, showed determination to get back into the staring lineup. She See HYBER, page 34

















continued from page 33 didn’t do too shabbily, leading the team with two goals and one assist. Sophomore Melissa Welch also scored as the Wolverines cruised to a 4-0 victory. Bandremer picked up her tenth shutout win of the year.
Playing in the third-place consolation game, the WHS girls needed penalty kicks to determine the winner. In a windy, chilly afternoon contest, neither WHS nor Gulliver Prep could score during regulation.
“Every time I tried to punt the ball, the wind would practically stop it completely; it was very irritating,” Bandremer said.
Puñal and senior Sarah Lenhart each played well in the first half. However, it was two defenders, senior Genny Rigg and sophomore Kaelin Ferreira, who broke up many passes that prevented Gulliver from gaining momentum. Bandremer contin-
ued to be the team’s backbone, letting nothing pass by her.
In the shootout, however, luck couldn’t have been worse for WHS. Seniors Lenhart and Ashlii Smith both hit the same right post in virtually the same spot. Unfortunately for the Wolverines, Bandremer, who is normally dominant in penalty kicks, was unsuccessful at stopping three Gulliver’ shot attempts. Although 1-1-1 for the tournament, the girls played progressively better as the games went along.
Boys Basketball — Head
Coach Matt Colin has quickly turned the boys varsity basketball season around after its 0-3 start. Sitting at 3-3, the Wolverines edged out rival Palm Beach Central on Friday, Dec. 19. Senior Rahiem Smalls and sophomore Scott Witkowski lead the team to a 51-49 victory.
Witkowski had a team-high 14 points and eight assists while backcourt companion Mike Randell had a solid 10 points. Smalls was three rebounds shy of a double-double, finishing with 11 points and seven re-








bounds. Senior Milton Cook played well, scoring a seasonhigh seven points. The Wolverines were set to play two games this past week at the Mitchell Holiday Tournament. Results were not available at press time.


Saturday, Dec. 27
• Ballet Florida will continue Marie Hale’s The Nutcracker at the Kravis Center for the Performing Arts (701 Okeechobee Blvd., West Palm Beach) through Sunday, Dec. 28 in the Dreyfoos concert hall. Call (561) 832-SHOW or visit www. kravis.org for more info.
• The Ringling Bros. and Barnum & Bailey Circus will continue at the South Florida Fairgrounds (9067 Southern Blvd.) through Tuesday, Dec. 30. Circus-goers will enjoy an up-close and personal experience as they sit just feet away from white tigers, Asian elephants and thrilling acrobats. Tickets are on sale at www. ringling.com, www.ticket master.com or by calling Ticketmaster at (561) 966-3309.
• The Kravis Center for the Performing Arts (701 Okeechobee Blvd., West Palm Beach) will continue Forbidden Broadway Wednesday, Dec. 31 in the Rinker Playhouse. Call (561) 832-SHOW or visit www.kravis. org for more info. Sunday, Dec. 28
• The Loxahatchee Chapter of the Florida Trail Association will explore the trail system behind the Solid Waste Authority’s administration building (Jog Road north of 45th Street) on Sunday, Dec. 28. Meet at the parking area at 7:30 a.m. For more information, call Alan at (561) 5860486.
• The Wellington branch of the Jewish Community Center of the Greater Palm Beaches (13889 Wellington Trace, Suite A-15) will hold a Family Hanukkah Party from 10 a.m. to 2 p.m. on Sunday, Dec. 28. Come to the JCC for a fun-filled, festive family celebration featuring a bounce house, kids’ yoga, face painting, puppet show, dreidels, jelly doughnuts, music, crafts and more. The cost will be $18 per family. For more information, or to register, call (561) 253-6030.
Monday, Dec. 29
• The Wellington branch of the Jewish Community Center of the Greater Palm Beaches (13889 Wellington Trace) will hold “Winter Break Music and Movement and Arts and Crafts” on Monday, Dec. 29 through Wednesday, Dec 31. Drop children off for two hours of fun. Hours will be 10 a.m. to noon for ages three through five and 12:30 to 2:30 p.m. for ages six through eight. Class will begin with high energy movement and music and finish with hands-on art activities taught by an experienced preK teacher. The fee will be $60 for three days. For more information, or to register for the event, call Elizabeth at (561) 253-6030.
• The Wellington library (1951 Royal Fern Drive) will hold a Poetry Recital on Monday, Dec. 29 at 6:30 p.m. for families and children ages four and up. Young performers will recite animal poems, funny poems, nature poems and more. Call (561) 790-6070 for more info. Thursday, Jan. 1
• The Loxahatchee Chapter of the Florida Trail Association will start the new year right with a walk in Hickory Hammock on Thursday, Jan. 1. Meet at 9 a.m. at the entrance of Highway 98, eight miles past the Kissimmee River. For more info., call Bea at (561) 9684864.
• The Kravis Center for the Performing Arts (701 Okeechobee Blvd., West Palm Beach) and Attila Glatz Concert Productions will present “Salute To Vienna: The World’s Greatest New Year’s Concert” in the Dreyfoos Concert Hall on Thursday, Jan. 1 at 8 p.m. Call (561) 832-7469 or visit www. kravis.org for more info. Friday, Jan. 2
• The Kravis Center for the Performing Arts (701 Okeechobee Blvd., West Palm Beach) will present “Blue: A Tribute to Joni Mitchell” in the Rinker Playhouse on Friday, Jan. 2 through Sunday, Jan. 4 Call (561) 832-7469 or visit www. kravis.org for more info.
• State Ballet Theatre of Russia will present “Giselle” at the Kravis Center for the Performing Arts (701 Okeechobee Blvd., West Palm Beach) on Friday, Jan. 2 at 8 p.m. Call (561) 832-7469 or go to www.kravis. org for more info.
Saturday, Jan. 3
• Enjoy the company of walkers with the Loxahatchee Chapter of the Florida Trail Association in John Prince Park on Saturday, Jan. 3. Walkers will meet at 7:30 a.m. and walk for about one hour before going to breakfast together. For more info., call Paul at (561) 963-9906.
• The Palm Beach Pops will present a tribute to the music of Dean Martin and Bobby
Darin at the Kravis Center for the Performing Arts (701 Okeechobee Blvd., West Palm Beach) on Saturday, Jan. 3 and Sunday, Jan. 4 at 8 p.m. in the Dreyfoos Concert Hall. Call (561) 832-7469 or visit www. kravis.org for more info.
Sunday, Jan. 4
• The Loxahatchee Chapter of the Florida Trail Association will hold a hike at Jonathan Dickinson State Park in Jupiter on Sunday, Jan. 4. Meet at the entrance gate at 8 a.m. for a nine-mile hike. Shorter hikes are available. Call Mary at (561) 391-7942 for more info.
Monday, Jan. 5 • Art lovers will be able to see stunning and realistic paintings of orchids at the American Orchid Society’s exhibition “Elegance in Bloom: The Watercolors of Sally Robertson,” which runs Jan. 5 through Feb. 1 at the AOS Botanical Garden (16700 AOS Lane, Delray Beach). The exhibit is free and open to the public. A reception featuring light refreshments is scheduled from 5 to 7 p.m. on Jan. 9. For more info., call (561) 404-2000 or visit www. aos.org.
• The Wellington library (1951 Royal Fern Drive) will present “Baby Story Time” on Monday, Jan. 5, 12 and 26 at 9:30 a.m. for infants under nine months and 11:15 a.m. for ages 10 to 18 months. Your baby will love the rhymes, finger plays, songs, books and toys. Call (561) 790-6070 to pre-register.
• The Wellington library (1951 Royal Fern Drive) will hold an English Exchange on Mondays, Jan. 5, 12 and 26 at 1 p.m. for adults. Practice English conversation skills with Literacy AmeriCorps member Paula Alexander. Basic Englishspeaking skills are required. Call (561) 649-5495 to preregister.
• The Loxahatchee Chapter of the Florida Trail Association will host a presentation on hiking the Appalachian Trail on Monday, Jan. 5 at 7 p.m. at the Okeeheelee Nature Center (7715 Forest Hill Blvd.). For more info., call Paul at (561) 963-9906.
• The Kravis Center for the Performing Arts (701 Okeechobee Blvd., West Palm Beach) will present “The Hugh Sung Trio: A Florida Debut,” with pianist Hugh Sung, accordionist Lidia Kaminska and saxophonist Doug O’Connor in the Rinker Playhouse on Monday, Jan. 5 at 7:30 p.m. Call (561) 8327469 or visit www.kravis.org for more info.
Wednesday, Jan. 7
• The 2009 Winter Equestrian Festival opens in Wellington on Jan. 7 and continues through March 29 with a series of weekly show jumping and dressage competitions at the Palm Beach International Equestrian Center (14440 Pierson Road, Wellington). Shows run Wednesday through Sunday culminating with a Sunday grand prix. For tickets, call (561) 793-5867 or visit www.equestriansport.com.
• The Wellington library (1951 Royal Fern Drive) will present the book discussion series Discover the World on Wednesday, Jan. 7 at 6:30 p.m. for adults. Sara Harris will lead a discussion of Bel Canto by Ann Patchett. Sign up and check out the book. Call (561) 790-6070 for more information.
Thursday, Jan. 8
• The 2009 polo season will open Thursday, Jan. 8 at the International Polo Club Palm Beach with the kickoff of the 20-goal Joe Barry Memorial Cup. The Joe Barry tournament continues until Sunday, Jan. 18. The International Polo Club is located at 3667 120th Avenue South in Wellington. For tickets, brunch reservations or more information, call (561) 204-5687 or visit www.inter nationalpoloclub.com.
• The Wellington library (1951 Royal Fern Drive) will present “Young Artists Series: Dot It!” on Thursday, Jan. 8 at 3:30 p.m. for ages five through eight. Paint a picture with dots using Q-tips. Dress appropriately. Call (561) 790-6070 to pre-register.
• The Wellington library (1951 Royal Fern Drive) will present “Pizza & Pages: The Book Thief” on Thursday, Jan. 8 at 6:30 p.m. For ages 12 to 17. Participants will discuss The Book Thief by Marcus Zusak. Copies will be available at the children’s desk. Pizza will be provided by the Friends of the Library. Call (561) 7906070 to pre-register. Send calendar items to: The Town-Crier, 12794 W. Forest Hill Blvd., Suite 31, Wellington, FL 33414. FAX: (561) 7936090. E-mail: news@gotown crier.com.



















































By Ron Bukley Town-Crier Staff Report
Locally owned Kookaburra’s Pet Supply has come to be known as a health food store for pets.
“We carry the holistic, organic, grain-free,” owner Peggy Lenzi. “You can tell by the food we carry, organic lines, plus we carry the raw diet in the freezer there.”
Kookaburra’s stocks foods that are a breed apart from those offered in supermarkets.
“Many of our customers tend to be big-time animal lovers who really want the best for their pet, so we offer them a good selection of healthy foods,” she said. “They can come in here and buy for their horse, their dog and their cat. We love label readers. We have customers turning cans and reading ingredients. There’s nothing better than to see someone come in, look at the ingredients and see what’s actually in it. We offer no grocery store brands, which I feel would be against what this store is really about.”
Located in the Kmart shopping plaza in Royal Palm Beach, Kookaburra’s offers more than 10,000 items in its 10,000 square feet of space. “People are surprised at how big the store actually is,” Lenzi said.
Kookaburra’s is one of the few independent pet supply operations in the area. “We have our long list of loyal customers to thank for our success,” Lenzi said. “We try to show our customer appreciation by our everyday competitive pricing. Our customers constantly comment on how good our pricing is.”
Lenzi is especially proud of her bird department, where birds are hatched and raised. “They are hand-fed and raised there in the nursery,” she explained. “What that means to the customer is it gives the customer a bird with a really sweet personality and great temperament. We have everything from the parrotlets, which is a mini parrot, to the macaws.”
Kookaburra’s also has small birds such as songbirds and parakeets, also raised in the store. “We even have our own kookaburra,” Lenzi said. “That’s what the store is named after.”
The Australian kookaburra has a call that resembles the sound of human laughter, Lenzi said. “In the early morning, he’ll sound off and it actually sounds almost like he’s laughing,” she said.
Kookaburra’s features aisles and aisles of horse products and supplements. The store also carries small animals and reptiles, cages, bedding and appropriate foods.
“We even carry marmoset food, all the bulk foods, sugar glider foods, ferrets, hedgehogs, all that stuff,” Lenzi added.
The store carries products from smaller vendors that can’t be found anywhere else, Lenzi said. It has an extensive line of dog and cat foods, including more than 25 different dog food brands alone — and customers are impressed at the variety.
“Because we deal with some of the smaller vendors, there’s a lot of stuff you can’t find because they’re privately owned small companies,” she said.
One bird toy manufacturer actually makes his products by hand and won’t sell them through the giant retailers, Lenzi said.
Kookaburra’s carries both fresh and saltwater fish and holds what Lenzi calls “washout Wednesday,” when all the fish coming in are 25 percent off. “That has been a big hit, and it has really helped with this economy,” she said.
Kookaburra’s also carries aquatic plants and tanks, and can special order tanks it does not have immediately available. “If it’s something we don’t carry in the store, we’ll special order it for them. When we get it in, we’ll sell it just above cost, so that’s been a big hit,” Lenzi said. “We’re trying to fight back with the economy the way it is. It has been tough for all of us.”
Owning a pet store is a dream come true, Lenzi said, having owned horses, dogs, cats and reptiles all her life. “When I was a kid, I really wanted to become a veterinarian,” she said.
The store has been in the area 14 years, and in the same location for 10. Lenzi bought the store almost three years ago from the original owner when he retired.
“It’s a lot of work, probably more than I anticipated, but the rewards, just with the customer base, people who have been coming here ten years, it warms your heart when they tell you, ‘I wouldn’t go anywhere else.’ We have staff member who have worked here for years.”
The store owes its continued existence to its loyal customer base, and Lenzi said she tries to reciprocate. “We make every attempt in our power to do special orders, and when they come in here they don’t feel like just a number. I think that’s why we have survived for so long.”
The recently completed Southern Blvd. roadwork and renovations at the shopping center itself has left Kookaburra’s feeling a bit isolated.
“It would be nice if more people knew we were here, because we are kind of shut off,” Lenzi said. “When people walk in they are surprised. They can’t believe all the products at competitive prices. I think a lot of people think if you’re not a big-box store, that you can’t compete, and actually we compete quite well.”
Kookaburra’s web site at www.kpetsupply.com lists the store’s products and prices. “The web site is fairly new,” Lenzi said. “We have the products listed but we haven’t updated the photographs yet.”
Kookaburra’s Pet Supply is located at 10329 Southern Blvd. at the corner of State Road 7 in Royal Palm Beach and is open Monday through Saturday from 9 a.m. to 6 p.m. and Sunday from 10 a.m. to 6 p.m. For more info., call (561) 790-6612.
‘We have our long list of loyal customers to thank for our success. We try to show our customer appreciation by our everyday competitive pricing. Customers constantly comment on how good our pricing is.’ — Kookaburra’s owner Peggy Lenzi






Palm Beach County Clerk Sharon Bock presented a total of $42,500 to 25 different charities during a Dec. 17 ceremony at the Palm Beach County Courthouse. The money is raised annually through the Clerk & Comptroller’s Dress Down Friday Charity Program, which gives employees the option of contributing $2 a week from their paychecks to dress casually on Fridays. Charities are selected by the roughly 400 employees who participate in the program and 100 percent of the funds raised are split equally among the nonprofit organizations.
“Every dollar counts for these
charities, especially during these tough financial times,” Bock said. “While studies show that a downturn in the economy causes people to give less, this does not reflect what’s happening here in the heart of the clerk’s office. This year, our team contributed $3,000 more than last year!”
The clerk’s office has donated more than $530,000 to charities since the Dress Down program began in 1994. The following organizations received donations this year: Aid to Victims of Domestic Abuse, Alzheimer’s Community Care Association, American Heart Association, American Lung Associ-
ation, American Parkinson’s Disease Association, The ARC of Palm Beach County, Association for Abused Women and Children, Busch Wildlife Sanctuary, Children of Purpose, Children’s Place at Home Safe, Comprehensive AIDS Program, Kids in Distress, Florida Resource Center for Women & Children, Hospice Foundation of Palm Beach, Hospice & Home Care by the Sea, Makea-Wish Foundation, National Center for Missing & Exploited Children, Paralyzed Veterans of America, Peggy Adams Animal Rescue League, Red Cross of Greater Palm Beach County, Safe Harbor Animal Rescue &
Clinic, Shriners Children’s Transportation Fund, Special Olympics of Palm Beach County, St. Jude’s Children’s Research Hospital and the Susan G. Komen Foundation. In addition, the annual Governmental Center performance of the clerk’s volunteer choir, Circuit Sound, raised $600 for the Special Olympics. The clerk’s office also donated nearly 40 used cell phones to Aid to Victims of Domestic Abuse and the YWCA Harmony House. Domestic violence victims can use the phones to call 911. For more information, call (561) 355-2996 or visit www. mypalmbeachclerk.com.
Deciding to purchase a home is one of the most significant decisions that a consumer will ever make. It is crucial that the consumer work with a licensed mortgage broker, loan originator or other mortgage professional during the home-buying process. While most mortgage industry professionals are honest and ethical, it is still important for consumers to be aware of the following tips as they prepare to enter the largest financial transaction of their lives. By becoming knowledgeable about the mortgage process, they can protect their financial investment and find a loan that will best serve their needs. The Florida Association of Mortgage Brokers (FAMB) offers the following tips to avoid abusive lending practices during the home-buying process:
• Shop around and compare — If you need to borrow money for a home purchase, refinance or home repairs, shop around with different licensed mortgage brokers and lenders. Compare interest rates and find out what the total costs of the loan will be and what your monthly payment will be before making a decision. You should be furnished with a good-faith estimate of costs. Use the goodfaith estimate from each licensed lender or broker to compare the loan terms and costs.
• Negotiate — Don’t let the promise of extra cash or lower monthly payments get in the way of your good judgment. Consider whether the closing costs you will pay for the loan are really worth it. Don’t agree to a loan that includes extra products you don’t want. Nego-
tiate the loan terms and agree to a loan amount that will meet your needs.
• Be cautious — Be wary of anyone who calls you on the phone, solicits you in the mail or comes to your door offering “bargain loans.” Beware of claims that the offer is only available for a short period of time. Beware of lenders claiming, “Bad credit? No problem.” If the loan terms seem too good to be true, perhaps they are.
• Never act immediately If the mortgage professional asks for fees up front, ask how the fees will be used and be certain to get the explanation in writing. Are the funds for the appraisal or credit report? Never pay a lender cash for any fees, and always make the check payable to the mortgage firm, not the individual loan officer.
• Understand the terms of your loan — Some loans may sound very attractive because the monthly payment is small. Ask if the payment will adjust during the life of the loan. Make sure you know the dollar amount of each monthly payment. If the loan is adjustable (ARM), make sure you understand how often and how much your payment can change.
• Don’t be afraid to ask questions — You have a legal right to know the total cost of the loan, the annual percentage rate (APR), the monthly payments and how long you will make payments on the loan. If you are unsure of any terms of the loan, ask for an explanation. If you don’t receive a straight answer, go elsewhere for your financing needs.
• Read carefully before you
sign — Don’t sign any document you haven’t read or has blank spaces that could be filled in after you sign. Don’t be pressured into signing any loan papers that you do not understand. If you need an explanation of any terms or conditions, talk to someone knowledgeable that you trust. Get copies of everything you sign at the time you sign them.
• Borrow only the amount you need and can afford to repay — Just because you qualify for a certain amount of money doesn’t mean you should borrow the maximum. Consider whether you can afford to make the payments. Determine exactly how much money you need, borrow only that amount, and find out exactly how much your monthly payment will be. If you are consolidating debt, make sure you will have enough money left after closing costs and loan payoffs to pay any other bills you would like to eliminate. • Immediately get help if you feel you have been victimized — Contact your local state reg-
The Wellington community knows where to go for a tasty meal, but what they may not know is that the Chick-fil-A restaurant at the Mall at Wellington Green does a whole lot more than just serve great food. As part of its corporate purpose, Chick-fil-A restaurants nationwide strive to have a positive influence on all who come in contact with the company. Locally, the Chick-fil-A
in the Mall at Wellington Green has made an impact on area schools.
Since the beginning of this school year, the restaurant has donated more than $8,000 to Wellington schools. The restaurant regularly hosts Spirit Nights as fundraising events where 20 percent of the evening’s sales are donated to the participating school. Fundraising events also include a
spinning-wheel game to raise additional funds. The restaurant provides Chick-fil-A prizes at no charge to the organization, so every $1 donation to play the game goes directly to the fundraiser total.
“It is important to our Chickfil-A family to be involved in our local community, and Spirit Nights are a fun and easy way for an organization to gain support,” franchise operator
Rob Rabenecker said. “Depending on participation, the sky is the limit for how much can be raised at these events, and that money goes directly to the school. We want the Wellington community to know this unique fundraising opportunity is available, and we are here to help!” Fundraising events at the restaurant are not limited to schools. Non-profit organiza-
tions, community civic groups or local charities are also welcome to hold Spirit Nights at the Mall at Wellington Green Chick-fil-A.
“Fundraisers at Chick-fil-A are a fun way to involve the community to raise money for our school,” said P.J. D’Aoust, principal of Panther Run Elementary School, which holds monthly Spirit Nights at the restaurant. “Families always
have a great time, and Chickfil-A offers an inexpensive meal with healthy options. We are thankful to Rob and his team for being a generous partner in helping us host three Spirit Nights and raise more than $1,800 in much-needed funds for our school.” To organize a fundraiser to benefit your cause or organization, call Angela Bloom at (561) 271-0940.
Send business news items to: The Town-Crier, 12794 W. Forest Hill Blvd., Suite 31, Wellington, FL 33414. Fax: (561) 793-6090. E-mail: news@goTownCrier.com.




Jumpin’ Juice & Java in Boynton Beach recently held a networking mixer Thursday, Dec. 11. Participating businesses included Jumpin’ Juice & Java, Copper Tan, Renaissance Commons, Pei Wei Asian Diner and Smile Wave Day. Proceeds went toward the Bennie Blades Foundation (www.bennieblades36foundation.com). For more information about Jumpin’ Juice & Java, call (561) 752-5282 or visit www.jumpinjuiceandjava.com.




The Board of Commissioners of the Health Care District voted unanimously Dec. 10 for “Lakeside Medical Center” to be the name of the new 70-private bed hospital in western Palm Beach County on track for completion in the fall of 2009.
“This name captures what this new hospital is all about — a modern medical facility that has been strategically situated to serve all the communities which hug the southeastern shores of Lake Okeechobee,” Board Chair Jonathan R. Satter said. Lakeside Medical Center is being constructed on a 50-acre site at the intersection of US 441 and State Road 80, centrally located with easy access from Belle Glade, Pahokee and South Bay. “Lakeside Medical Center reflects a new beginning, and we feel the name conveys that forward-looking, positive view,”
said Bryan Cross, chair of the Glades General Hospital Board. “The name Lakeside Medical Center represents all of our communities.”
The Health Care District designed Lakeside Medical Center with the comfort, privacy and safety of patients, families and visitors in mind. All inpatient rooms are single-occupancy. In addition, there are family-friendly consultation rooms and an enhanced Emergency Room to swiftly and efficiently treat patients. The ER also has direct access to a large helipad to facilitate Trauma Hawk and other aeromedical transport.
To promote care and comfort for new mothers, their babies and their families, the new hospital features six private labor and delivery rooms and a dedicated area for ten private postpartum rooms.



“Lakeside Medical Center will further advance the district’s mission of ensuring access to a comprehensive healthcare system and delivering quality services for Palm Beach County residents,” Health Care District Chief Executive Officer Dwight D. Chenette said. More than just a medical campus, Lakeside Medical Center will establish a new community hub for the surrounding area.

The large medical campus provides ample space for future expansion.
The Health Care District has committed $53 million toward the $73 million hospital. The Glades Healthcare Foundation, a non-profit organization, is leading the capital campaign to raise additional funds. If you wish to donate to the campaign, visit www.gladeshealthcare.org or call (561) 833-8999.




Margaret, owner of Hair Spray the Salon, welcomes professionals from Spa at Wellington Green, including Oneina, Samantha, Cheri, Spring and Nikki as well as Jago and Lorraine, who joined her from Salon Soliel, and Sandy from Sophie’s Choice. Together with her current staff, Nancy, John and Vicky, Margaret looks forward to continuing to offer fullservice salon expertise including color, waxing, facials, manicures, pedicures and eyelash extensions, plus much more. Hair Spray the Salon is open 9 a.m. to 6 p.m. six days a week with late nights on Wednesday and Thursday until 8 p.m. Stop by and meet the salon’s professionals, 11932 Forest Hill Blvd., in the Wellington Town Square. For more information, or to schedule an appointment with your favorite stylist, call Hair Spray the Salon at (561) 798-9177.
A gift-gathering party to support the Wellington Rotary Club’s March gala will be held on Friday, Jan. 16 at 7 p.m. at the home of event chair Karen Hardin (9847 Royal Cardigan Way, Wellington). For more information, call Hardin at (561) 324-1149 or e-mail kjhsedona@aol.com.











































ARMENTO PAINTING & SONS, INC. –– Painting, Interior, Exterior. Pressure cleaning. Custom painting, faux art. Lic. No. U14736. 798-8978. BD JOHN PERGOLIZZI PAINTING INC. ––– Interior/Exterior, artistic faux finishing, pressure cleaning, popcorn ceiling, drywall repair, & roof painting/cleaning. Free est. Call 798-4964. Lic.#U18473 LET US AD A LITTLE COLOR TO YOUR LIFE — Residential/Commercial. Licensed • Bonded • Insured. Owner/Operator. Ask for Paul 561-3098290. COLORS BY CORO, INC. — Interior/ Exterior, residential painting, over 20 years exp. Small Jobs welcome. Free estimates - Insured. 561-383-8666. Owner/Operated. Lic.# U20627 Ins. Wellington Resident. PAINTING — HOME PAINTING Interior - Exterior. $1290 +tax up to 2500 sq. ft. (walls area) 561-674HOME(4663) Masterpiece Painting Contractors Inc. CC U#21111 Lic./Ins. CREATIVE PAINTING SYSTEMS, INC. — Interior • Exterior • Residential Specialists. WE DELIVER WHAT WE PROMISE. All work guaranteed. FREE ESTIMATES. Family owned & Operated. Over 23 years experience. License #U-18337 • Bonded • Insured Owner/Operator George Born. 561686-6701 DECORATIVE PAINTING — "We Paint to Sell or Enjoy Nicer Living" Fair price, quick, neat and honest. 561-633-9418.
IDEAL ROOFING SYSTEMS — Residential • Commercial • Licensed Bonded • Insured. New Construction Reroofs • Repairs • Roof Tile • Shingles Metal Roofs • Flat Decks • MaintenanceContracts info@idealroofingsystems.com. Palm Beach/Broward Office: 561753-7663 Fax: 561-753-7696. St. Lucie/Indian River. Office: 772-2886440. Fax: 772-287-9008. 11101 S. Crown Way #6, Wellington, FL 33414. Lic. #CCC1326453 HORIZON ROOFING QUALITY WORK & SERVICE — Free estimates, No Deposits. Pay upon completion, residential, commercial, reroofing, repairs, credit cards accepted.561-8426120. Lic.#CCC1328598
JOHN’S SCREEN REPAIR SERVICE — Pool & patio rescreening. Stay tight,wrinkle-free,guaranteed! CRC1329708 798-3132.
ALUMINUM
ALL TYPES — Pinewood Construction, Inc. Honest and reliable. Serving Palm Beach County for over 20 years. Call Mike 561-309-0134 Lic. Ins. Bonded. CGC-023773 RC-0067207 CLASSIFIEDS ADS GET RESULTS ADVERTISE HERE CALL 793-3576 TO PLACE YOUR AD HERE! WWW.GARABAR.COM — Now is the time for the Best Prices. Re-roof & Repairs. No Deposit Until Permit Credit cards accepted. Free Estimate. 561-337-6798. Lic.#CCC1327252 & CGC1510976

























































